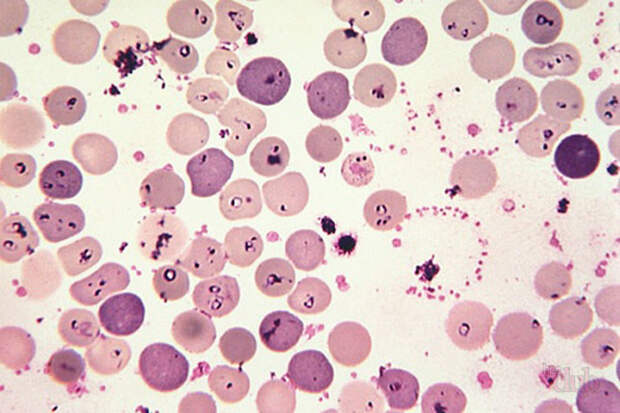

Пироплазмоз (бабезиоз) собак: симптомы, диагностика, лечение
Известны два вида Babesia, способные инфицировать собак:
- Babesia canis и Babesia vogeli, которые также известны как «крупные бабезии».
- Babesia gibsoni и Theileria annae, близкий к Babesia microti вид, называемые «малыми бабезиями».
Бабезии инфицируют эритроциты, в которых можно обнаружить мерозоиты возбудителя. Они представляют собой грушевидной, субсферической или округлой формы паразитов, которые в клетке могут располагаться парами или одиночно.
Несколько видов Babesia были описаны в различных европейских странах: B. canis, B. vogeli, Theileria annae и B. gibsoni. Они представляют собой грушевидной, субсферической или округлой формы паразитов, которые в клетке могут располагаться парами или одиночно.
Препатентный период короткий, длится 4–20 дней, а иногда даже может составлять 1 или 2 дня. Стоимость лечения собаки можно посмотреть в нашем прайс-листе.
Патогенез заболевания
Особенности патогенеза зависят от нескольких факторов:
- От паразита: вирулентность изолята, произошло ли первичное инфицирование или реинфекция, инфицирующая доза.
- От хозяина: молодые животные или те, у которых имеются сопутствующие заболевания, или те, кто не имел ранее контактов с этим паразитом при попадании в эндемичный район, являются более восприимчивыми к заболеванию, а течение болезни у таких животных проходит в более тяжелой форме.
Патогенез одинаковый для различных видов Babesia:
- Механическое воздействие: разрушение эритроцитов в результате размножения трофозоитов внутри этих клеток. Это приводит к тяжелой анемии (внутрисосудистый гемолиз), которая сохраняется в течение паразитемии.
- Увеличение сосудистой проницаемости приводит к развитию отеков, вазодилатации, артериальной гипотензии и застою крови, что ведет к метаболическому ацидозу, который усугубляет течение болезни.
- Эритроциты прилипают к эндотелию кровеносных сосудов, вызывая риск развития тромбозов.
 Процесс усугубляется образованием иммунных комплексов, которые осаждаются на мембране инфицированных эритроцитов и в некоторых тканях.
Процесс усугубляется образованием иммунных комплексов, которые осаждаются на мембране инфицированных эритроцитов и в некоторых тканях.
Возможно развитие различных клинических исходов заболевания, в зависимости от поражаемого органа (печени, почек, легких, скелетной мускулатуры или сердца, ЦНС).
Эпидемиология
Сезонность заболевания связана с климатическими потребностями его переносчиков — иксодовых клещей.
Основные источники инфекции
- Инфицированные бабезиозом клещи.
- Больные животные.
- Клинически здоровые носители, обитающие в эндемичных районах.
Менее распространенные, пути заражения бабезиозом
- Переливание крови.
- Хирургический материал.
- Вертикальная передача и передача от собаки к собаке (инфицирование животных описано для В. gibsoni после укуса инвазированной собакой).
Клинические признаки (симптомы) бабезиоза собак
- Гипертермия (выше 41 °C).
- Астения, анорексия, потеря массы тела.
- Дегидратация.
- Желудочно-кишечные расстройства (рвота, диарея).
- Гепатоспленомегалия, отеки, асцит, желтуха, геморрагии на коже и слизистых оболочках, одышка, бледность, боли в мышцах, парезы, атаксия.
- Клинико-патологические изменения: нормохромная, нормоцитарная, нерегенеративная анемия, нейтропения, тромбоцитопения и гемоглобинурия.
Развитие симптомов бабезиоза (пироплазмоза)
Развитие клинических признаков зависит от вида паразита, возраста животного, гигиены и условий питания. Препатентный период короткий, длится 4–20 дней, а иногда даже может составлять 1 или 2 дня.
- У молодых животных клинические признаки бабезиоза, как правило, протекают остро, с препатентным периодом в 4–6 дней и патентным
- периодом от 7 до 10 дней. В этой возрастной группе бабезиоз может оказаться смертельным.
- У взрослых животных, как правило, чаще возникает обострение хронического течения болезни на фоне ослабления иммунной системы.

Сезонность заболевания связана с климатическими потребностями его переносчиков — иксодовых клещей.
Диагностика бабезиоза (пироплазмоза) собак
Клиническая диагностика основывается на данных клинического осмотра и результатах лабораторных исследований.
Специфическая диагностика
Исследование мазка крови, методы молекулярной диагностики и серологические методы исследования.
- В окрашенных мазках крови: трудно обнаружить паразитов из-за ограниченного периода паразитемии. Тонкие мазки приготавливают из периферической крови (кончик уха, капиллярная кровь из когтя).
- Молекулярная диагностика: ПЦР, особенно в случаях низкой паразитемии и для определения вида Babesia.
- Серологические методы не считаются методами выбора в связи с перекрестной реактивностью, главным образом между B. сanis и В. gibsoni. Перекрестные реакции могут возникать и между остальными видами бабезий, что затрудняет интерпретацию. Кроме того, невозможно точно установить, является ли это результатом прошлой инвазии или настоящей. В любом случае, эти методы удобны для исследования образцов при выздоровлении и исследования образца, повторно взятого через 3-4 недели с целью оценки сероконверсии.
Лечение бабезиоза (пироплазмоза) собак
- Пироплазмициды: имидокарб дипропионат. Эффективен в лечении инвазий, вызываемых Babesia canis и Babesia vogeli. Также применяется для профилактики. Важно не путать с вакцнацией (прививкой) от пироплазмоза!
- Препараты против инвазии Theileria annae: атоваквон и бупарвакон.
- Поддерживающая терапия: в зависимости от клинических признаков и изменений лабораторных показателей.
- Могут быть использованы другие лекарственные препараты, например, фенамедин, пентамидин или диминазен, но они достаточно токсичны и
- имеют низкую эффективность.
- В некоторых случаях показано назначение доксициклина и клиндамицина.

Профилактика и контроль бабезиоза (пироплазмоза) собак
Для профилактики бчабезоза (пироплазмоза) собак применяется вакцина против B. canis — Пиродог компании Мериал, изготовленные на основе растворимых паразитарных антигенов от простейших, выращенных на специфических культурах.
Вакцина (прививка) от пироплазмоза Пиродог
Вакцина Пиродог эффективна для профилактики бабезиоза собак. Даже в случае заболевания вакцинированной Пиродогом собаки, существенно снижается тяжесть заболевания пироплазмозом.
Щенков можно вакцинировать с 5-месячного возраста, с повторной ревакцинацией через 3-4 недели. Далее вакцинация Пиродогом проводится каждые полгода (для эндемичных районов) или ежегодно.
Как и на другие вакцины возможно появление общих иоли местных нежелательных реакций, которые по своим свойствам не отличаются от реакций после введения других вакцин. Иногда можно услышать о негативном влиянии вакцинации Пиродогом на печень или другие органы.
Такое мнение вызвано тем, что с вакцинацией путают введение пироплазмицидов, что абсолютно не верно. Наиболее оптимальное время для вакцинации Пиродогом — зима и лето.
Важно помнить, что как и другие прививки, Пиродог начинает «действовать» спустя время. Иммунитет образуется через 2-3 недели после вакцинации. Прививку Пиродог можно комбинировать с применением препаратов, защищающих от клещей и блох.
Для предотвращения инвазии Babesia spp. важно регулярно применять собакам акарициды. Нужно убить клеща до того как он успеет заразить собаку. Так как заражение бабезиозом происходит не сразу после начала питания клеща, а спустя примерно 48 часов, существует высокая вероятность защиты собаки от пироплазмоза с помощью различных препаратов.
Капли (спот-он) от клещей для собак
Сертифект спот-он — обладает экспеллентным эффектом, влияющем на возможность питания клеща: клещи не могут прикрепиться, даже если успеют, открепляются сами.

Доказана защита собаки не только от бабезиоза, но и от анаплазмоза, эрлихиоза и боррелиоза, заболеваний, которые также передаются собакам клещами. Сертифект Спот-Он хороший препарат, но он требует очень корректной и правильной обработки, в противном случае у собаки можно наблюдать вялость и аппатию после его применения.
Если вам нужен мощный препарат против клещей и вы готовы неукоснительно соблюдать инсторукцию, то обратите внимание на Сертифект. В ином случае — используйте другие препараты.
Фронтлайн Три-Акт — новинка 2016 года. Препарат для топикального нанесения (капли), обладает репеллентными свойствами против клещей: клещ попадает на собаку, но благодаря репеллентному действию не может прикрепиться к собаке, а значит не может заразить собаку пироплазмозом.
Доказано снижение риска передачи бабезиоза и пироплазмоза при регулярном применении Фронтлайн Три-Акт собакам. Помимо клещей и блох Фронтлайн Три-Акт отпугивает от собак комаров, москитов и кровососущих мух. Комары и москиты не просто неприятные паразиты, они заражают собак дирофиляриозом (комары) и лейшманиозом (москиты).
Если вы не хотите видеть на собаке блох, клещей и летающих насекомых обратите внимание на данный продукт.
Таблетки от клещей для собак
Новая форма защиты собак от клещей и блох. Фронтлайн Нексгард — вкусная таблетка для собак, которая в течение месяца защищает от клещей и блох собаку. Препарат очень легко применить — можно дать с кормом или просто как лакомство — в большинстве случаев собаки сами его съедят.
Фронтлайн Нексгард быстро начинает действовать — максимум через 4 часа после приема собака полностью защищена (у капель полная защита обычно начинается через 24 часа после применения, у ошейников может занять 1-2 недели).
Непривычно видеть препарат против клещей и блох, который нужно применять внутрь, но он ействительно работает. Конечно, клещ или блоа должны сначала укусить собаку, но благодаря системному действию гибель паразита наступает очень быстро: первые блохи погибаю уже через 30 минут после попадания на собаку.
Клещи начинают погибать уже спустя 4 часа, хотя нормой для всех препаратов считается, если более 90% блох погибнут в первые 24 часа и более 90% клещей за 48 часов. Эти нормы с легкостью перекрывает Фронтлайн НексгарД.
Безопасность препарата на высоте: при правильном применении нежелтельных реакций как правило не возникает. Препарат, как и другие средства, проверен при передозировке в несколько раз, не обладает тератогенным и эмбриотоксическим эффектом. Можно применять беременным собакам под контролем врача.
Спреи от клещей для щенков
Если ваша собака по возрасту менее 2х месяцев и/или весит менее 2х килограмм — рекомендуется обработка Фронтлайн Спреем. Фронтлайн спрей показан щенкам со второго дня жизни. Действует сразу после обработки. Важно правильно нанести спрей на собаку для максимального эффекта.
* Перед применением любого ветеринарного препарата обязательно прочтите инструкцию. возможны побочные эффекты.
Пироплазмоз у собак: симптомы, признаки и лечение
Что такое пироплазмоз?
Пироплазмоз собак (более научное название — бабезиоз собак или бабезиоз плотоядных) — заболевание, которое вызывается возбудителем Babesiacanis (в некоторых источниках Piroplasmacanis).
Возбудитель относится к типу простейших (это одноклеточные животные организмы микроскопических размеров) и паразитирует в крови животного. Если сказать более точно, то поселяется возбудитель пироплазмоза собак непосредственно в эритроците (красной кровяной клетке). Пироплазмоз собак проникает туда и, по сути, использует эритроциты собаки как домик-убежище, в котором питается и размножается.
Как возбудитель пироплазмоза собак попадает в организм?
Основные переносчики пироплазмоза собак — клещи. Те самые клещи, которые подстерегают наших любимцев не только в лесах и полях, но также и на чахлой травке и кустиках городских дворов и улиц. Они сидят и терпеливо ждут свою жертву.
Если клещу удалось попасть на животное, то он активно ищет место и «кусает его», то есть внедряет в кожу собаки ротовой аппарат и сосет кровь. При этом тело клеща остается снаружи и увеличивается в несколько раз (раздувается) по мере наполнения кровью. Именно в это время из слюнных желез клеща возбудитель пироплазмоза собак попадает в кровь собаки.
Некоторые владельцы считают, что такой клещ может «залезть» под кожу, это неверно.
Какие клещи опасны?
Самый часто встречающийся в средней полосе род клещей — Dermacentor, вид Dermacentor reticulatus (луговой клещ). Переносит такое известное заболевание как пироплазмоз собак, а также менее известное — эрлихиоз. Кроме того, по некоторым источникам он же способен переносить гемобартонеллез.
Второй по популярности – род Ixodes, клещи Ixodesricinus (собачий клещ) и Ixodespersulcatus (таёжный клещ) распространены на всей территории России, исключая север Сибири. Они являются переносчиками анаплазмоза и боррелиоза, а так же клещевого энцефалита, кроме того, поступает информация, что данный род переносит и пироплазмоз.
Третий род клещей– Rhipicephalussanguineus (коричневый собачий клещ) – живёт на юге, но может размножаться в квартирах, вольерах и будках. Переносит боррелиоз, эрлихиоз и пироплазмоз.
Обязательно ли собака заболеет пироплазмозом, если ее укусил клещ?
Нет. Не каждый клещ несет в себе возбудитель пироплазмоза собак.
Что происходит при попадании возбудителя пироплазмоза в организм собаки?
Проникнув в кровь собаки, паразиты начинают активно размножаться бесполым путем, то есть делятся на 2 — 4 и более особи. В результате эритроцит разрушается, простейшие высвобождаются, заселяют новые кровяные клетки. В процесс вовлекается огромное количество эритроцитов. По некоторым данным может быть поражено от 0,2 до 45%(!) эритроцитов.
Сами паразиты, продукты их жизнедеятельности, вещества разрушенных клеток оказывают токсичное действие на организм собаки.
Многие органы и системы перестают нормально функционировать. Нарушается обмен веществ и кроветворение. В ответ на действие токсинов усиливается функция сердечно-сосудистой и дыхательной системы. Из-за повышенной нагрузки деятельность этих органов может ослабевать, вызывать кислородное голодание и застойные явления, вплоть до отека легких.
Токсины, воздействуя на сосуды, усиливают их проницаемость, что может приводить к отекам и кровоизлияниям.
При разрушении эритроцитов высвобождается большое количество гемоглобина, часть которого выводится почками (из-за этого моча может приобретать красный или коричневый цвет), а часть превращается в желчные пигменты (билирубин), что может приводить к желтухе.
Воздействие токсинов на почки и печень очень губительно и может привести к почечной и печеночной недостаточности.
Какие признаки заболевания пироплазмозом у собак?
- Симптомы болезни могут быть ярко выраженными или наоборот стертыми.
- Обычно у больных пироплазмозом собак наблюдается вялость, снижение аппетита, повышение температуры тела.
- Часто (но не всегда!) изменяется цвет мочи. Она может быть красноватой, коричневой, желто-коричневой с различными вариантами оттенков.
- Довольно часто наблюдается желтушность кожи и слизистых оболочек.
- Возможен жидкий стул.
- Иногда возникает шаткость походки или хромота на задние конечности.
- В некоторых случаях пироплазмоз у собак протекает бессимптомно или со слабо выраженными признаками.
Насторожить владельцев должны: вялость, быстрая утомляемость, снижение аппетита, потеря веса.
Как скоро после укуса клеща могут проявиться признаки пироплазмоза у собаки?
Обычно клинические признаки у собак появляются через несколько дней после заражения (5-10 дней). Но возможно более раннее или позднее проявление симптомов.
Но возможно более раннее или позднее проявление симптомов.
Может ли собака заболеть пироплазмозом, если клещ ее не кусал?
Нет, но иногда владельцы могут не замечать клеща на собаке. В таком случае клещ, напившись крови, через несколько дней отвалится, а владелец животного будет думать, что его не было.
Симптомы бабезиоза (пироплазмоза) у собак
В последние годы отмечаются случаи, когда бабезиоз у собак протекает без характерных клинических признаков и без летального исхода. Однако, при исследовании мазков крови, окрашенных по Романовскому-Гимза, обнаруживаются бабезии. Это указывает на носительство возбудителя. Диагноз, как правило, ставится совершенно иной: от отравления до цирроза печени. Особый интерес представляет бабезионосительство среди беспризорных городских собак.
Наличие свободно циркулирующего возбудителя Babesia canis в популяции беспризорных собак является довольно серьезным звеном в эпизоотической цепи заболевания. Можно предположить, что данные животные являются резервуаром паразита, способствующим его сохранению. Таким образом, можно сделать вывод, что в популяции беспризорных собак сложилась устойчивая система «паразит-хозяин». Однако, на данном этапе невозможно определить, это случилось вследствие ослабления патогенных и вирулентных свойств Babesia canis или же за счет повышенной резистентности организма собак к данному возбудителю.
Бабезиоз собак протекает сверхостро (молниеносно), остро и хронически. Инкубационный период при заражении природным штаммом длиться 13-21 день, при экспериментальном заражении – от 2 до 7 дней.
При сверхостром течении болезни собаки гибнут без проявления клинических признаков. Поражение организма собаки Babesia canis при остром течении заболевания вызывает лихорадку, резкое повышение температуры тела до 41-42°С, удерживающееся в течение 2-3 суток, с последующим быстрым падением её до и ниже нормы (30-35°С). У молодых собак, у которых смерть наступает очень быстро, повышение температуры в начале заболевания может отсутствовать.
У собак отмечаются отсутствие аппетита, депрессия, угнетенное состояние, слабый нитевидный пульс (до 120-160 ударов в минуту), в дальнейшем становится аритмичным. Сердечный толчок усилен. Дыхание учащенное (до 36-48 в минуту) и затрудненное, у молодых собак часто со стоном. При пальпации левой брюшной стенки (за рёберной дугой) обнаруживают увеличенную селезёнку.
Слизистые оболочки ротовой полости и конъюнктива анемичны, желтушны. Интенсивное разрушение эритроцитов сопровождается нефритом. Походка становится затруднённой, появляется гемоглобинурия. Болезнь продолжается от 2 до 5 суток, реже 10-11 суток, часто со смертельным исходом (Н.А. Казаков, 1982).
В подавляющем большинстве случаев наблюдают гемолитическую анемию вследствие массового разрушения эритроцитов, гемоглобинурию (при этом моча становится красноватого или кофейного цвета), билирубинемию, желтушность, интоксикацию, поражение центральной нервной системы. Иногда отмечается поражение кожных покровов типа крапивницы, геморрагические пятна. Зачастую наблюдаются мышечные и суставные боли. Часто наблюдается гепатомегалия и спленомегалия. Может наблюдаться агглютинация эритроцитов в капиллярах головного мозга. При отсутствии своевременной помощи животные, как правило, погибают на 3-5 день болезни.
Хроническое течение часто наблюдают у собак, ранее переболевших бабезиозом, а также у животных с повышенной резистентностью организма. Эта форма болезни характеризуется развитием анемии, мышечной слабостью и истощением. У больных животных также отмечается повышение температуры до 40-41°С в первые дни болезни. Далее температура снижается до нормы (в среднем, 38-39°С). Животные вялые, аппетит снижен. Нередко появляются поносы с ярко-желтым окрашиванием фекальных масс. Продолжительность болезни 3-8 недель. Болезнь, как правило, заканчивается постепенным выздоровлением. (Н.А. Казаков, 1982 А.И. Ятусевич, В.Т. Заблоцкий, 1995).
Довольно часто в научной литературе можно встретить сведения о паразитоценозах: бабезиоз, анаплазмоз, риккетсиоз, лептоспироз и др. (А.И. Ятусевич и др., 2006 Н.В. Молотова, 2007 и др.). По данным P. Seneviratna (1965), из 132 обследованных им собак на вторичные инфекции и инвазии 28 собак имели паразитарное заболевание, обусловленное Ancylostoma caninum 8 – филяриоз 6 – лептоспироз 15 собак имели другие инфекции и инвазии.
(А.И. Ятусевич и др., 2006 Н.В. Молотова, 2007 и др.). По данным P. Seneviratna (1965), из 132 обследованных им собак на вторичные инфекции и инвазии 28 собак имели паразитарное заболевание, обусловленное Ancylostoma caninum 8 – филяриоз 6 – лептоспироз 15 собак имели другие инфекции и инвазии.
Павшие собаки истощены. Слизистые оболочки, подкожная клетчатка и серозные оболочки желтушны. На слизистой кишечника иногда имеются точечные или полосчатые кровоизлияния. Селезенка увеличена, пульпа размягчена, от ярко-красного до темно-вишневого цвета, поверхность бугристая. Печень увеличена, светло-вишневого, реже коричневого цвета, паренхима уплотнена. Желчный пузырь переполнен желчью оранжевого цвета.
Почки увеличены, отечны, гиперемированы, капсула легко снимается, корковый слой темно-красного цвета, мозговой – красного. Мочевой пузырь наполнен мочой красного или кофейного цвета, на слизистой оболочке точечные или полосчатые кровоизлияния. Сердечная мышца темно-красного цвета, под эпи- и эндокардом полосчатые кровоизлияния. В полостях сердца содержится «лаковая» не свернувшаяся кровь.
При сверхостром течении у павших животных обнаруживаются следующие изменения. Слизистые оболочки имеют легкую лимонную желтушность. Кровь в крупных сосудах густая, темно-красная. Во многих органах отмечаются четкие точечные кровоизлияния: в тимусе, поджелудочной железе, под эпикардом, в корковом слое почек, под плеврой, в лимфатических узлах, по верхушкам складок желудка. Наружные и внутренние лимфатические узлы набухшие, влажные, серые, с заметными фолликулами в корковой зоне. Селезенка имеет плотную пульпу, дающую умеренный соскоб. Миокард бледно-серый, дряблый. Почки также имеют дряблую консистенцию. Капсула легко снимается. В печени обнаруживаются признаки белковой дистрофии. Легкие имеют интенсивно-красный цвет, плотную консистенцию, в трахее часто обнаруживают густую красную пену. В головном мозге отмечается сглаженность извилин. В двенадцатиперстной кишке и передней части тощей слизистая оболочка покрасневшая, рыхлая. В остальных отделах кишечника поверхность слизистой покрыта умеренным количеством густой серой слизи. Солитарные фолликулы и пейеровы бляшки крупные, четкие, густо расположены в толще кишечника. Как особенность следует отметить отсутствие гемосидероза – показателя усиленного распада эритроцитов (В.Л. Лебедева, 1992).
В остальных отделах кишечника поверхность слизистой покрыта умеренным количеством густой серой слизи. Солитарные фолликулы и пейеровы бляшки крупные, четкие, густо расположены в толще кишечника. Как особенность следует отметить отсутствие гемосидероза – показателя усиленного распада эритроцитов (В.Л. Лебедева, 1992).
Читайте также:
Что такое бабезиоз и где обитают иксодовые клещи
Когда собака может заразиться бабезиозом
Бабезиоз у собак: диагностика
Бабезиоз у собак: лечение
Бабезиоз у собак: профилактика
Бабезиоз/пироплазмоз — симптомы, профилактика, лечение
Рассказывает врач интенсивной терапии, руководитель ОРИТ ветеринарной клиники “Эксвет” Юлия Гурина.
Когда говорят “клещ у собаки”, чаще всего имеются в виду иксодовые клещи — паразиты, живущие в траве в теплый период года. Именно с этими паразитами связан бабезиоз — заболевание собак, которое без своевременной помощи может быстро привести к смерти. Раньше в Одессе бабезиоз регистрировали крайне редко, в основном, у собак, которых вывозили за пределы города. Но в последние три года — очень часто.
Теперь по порядку.
Что такое бабезиоз
Бабезиоз (то же, что пироплазмоз) — это трансмиссивное (передающееся насекомыми и клещами, в данном случае клещами) заболевание. По сути это заражение внутриклеточными паразитами — бабезиями, которые попадают в кровь собаки при укусе клеща.
Бабезии опасны тем, что поражают и разрушают эритроциты. Возникает анемия, поражаются жизненно важные органы, в первую очередь, почки.
Иксодовые клещи Бабезии в эритроцитахСимптомы бабезиоза после укуса клеща у собаки следующие
- бледные или желтые слизистые оболочки,
- слабость,
- иногда рвота, диарея,
- концентрированный цвет мочи, вплоть до красно-коричневого,
- повышение температуры до 40° и выше,
- отказ от еды.

Диагностика бабезиоза
• мазок на бабезиоз. Бабезий легче всего обнаружить в мелких периферических капиллярных сосудах, поэтому кровь берем из сосудов ушной раковины.
- ПЦР-исследование на бабезиоз.
- клинические признаки.
Лечение собаки после укуса клеща в случае заражения бабезиозом
Бабезиоз лечится в зависимости от тяжести заболевания. Чаще всего лечение проходит в условиях отделения интенсивной терапии.
- Вводим препарат, убивающий бабезий (Пиро-стоп или Азидин). Препарат вводим дважды или более раз, в зависимости от тяжести заболевания.
- Проводим инфузионную терапию для коррекции обезвоживания, симптоматическую терапию.
- Проводим кислородотерапию. Это важно, потому что эритроциты – это те клетки крови, которые переносят кислород к органам, и если эритроциты разрушаются и их становится критически мало, кислорода внутренним органам не хватает для того, чтобы нормально выполнять свою функцию.
- В тяжелых случаях необходимо переливание свежей цельной крови или эритроцитарной массы. Делается это для того, чтобы восстановить количество эритроцитов в организме и улучшить кровоснабжение внутренних органов. Перед переливанием эритроцитов или свежей цельной крови нам необходимо проверить совместимость донора и реципиента. Для этого мы используем специальные тест-системы на группу крови. Благодаря тому, что в нашей клинике есть банк крови, мы можем питомцу оказать помощь в полном объеме.
- Постоянно мониторим общее состояние, проводим анализы – общий анализ крови, биохимические показатели почек, мазки крови на наличие паразита. Анализы проводятся для того, чтобы вовремя отреагировать на изменения в организме и скорректировать лечение, если требуется.
В среднем на лечение бабезиоза уходит от 2 дней до 3 недель. Как правило, прогноз от осторожного до благоприятного.
Как избежать бабезиоза
Профилактика заражения бабезиями — это профилактика клещей у собак. Регулярно обрабатывайте собак препаратами от клещей! Начинайте обработку заранее, до потепления температуры, а лучше — круглогодично. Не нарушайте график обработок, не дожидайтесь перерыва между обработками! Строго следуйте инструкции к препарату.
Регулярно обрабатывайте собак препаратами от клещей! Начинайте обработку заранее, до потепления температуры, а лучше — круглогодично. Не нарушайте график обработок, не дожидайтесь перерыва между обработками! Строго следуйте инструкции к препарату.
Самые эффективные на сегодняшний день — оральные формы препаратов (таблетки). Такой способ особенно актуален для питомцев, которые летом регулярно плавают. Это будет защищать собаку надежно и безопасно. Таблетки — Симпарика, Нексгард Спектра, Бравекто — покупайте только в специализированных, надежных местах продаж, опасайтесь подделок и нелегальных препаратов. Капли на холку Адвантикс, ошейник от клещей Форесто также надежные средства защиты при правильном применении.
Особое внимание обратите, когда вы с собакой выбираетесь на природу или на дачу. Если клещей очень много, используйте дополнительные средства защиты — аэрозоли. Обязательно регулярно осматривайте собаку на предмет клещей, которые обычно локализируются у основания ушей, или на ушах, в области подмышек, паха и на гениталиях.
Как действовать, если у собаки клещ
- Клеща нужно правильно снять — выкрутить. Крутить можно в любую сторону — по часовой стрелке или против. Можно использовать специальные выкручиватели клещей, которые продаются в зоомагазинах.
- Когда клеща извлекли, проверьте, достали ли его полностью, не оторвалась ли голова. Место укуса обработайте антисептиком (например, хлоргексидином), потому что может возникнуть местная реакция.
- Обязательно обратитесь к врачу! Это нужно для поиска других клещей на собаке, потому что не всегда владелец может заметить всех паразитов. Кроме того, врач возьмет мазок на бабезиоз. Причем это нужно делать как сразу, так и на 3, 5, 7 день. Не в каждом мазке крови можно сразу обнаружить бабезий. В начале заболевания, когда они не успели размножиться, найти их непросто. При обнаружении бабезий собаке проведут соответствующее лечение.
Будьте внимательны к своим питомцам!
Пироплазмоз 2019: продление сезона заболевания и атипичные формы проявления
Возбудители пироплазмоза – Babesia Canis и Babesia Gibsoni. Жизненный цикл пироплазм проходит со сменой двух хозяев – это иксодовый клещ и собака. Заражение собак происходит при укусе клеща, содержащего в себе бабезий.
Жизненный цикл пироплазм проходит со сменой двух хозяев – это иксодовый клещ и собака. Заражение собак происходит при укусе клеща, содержащего в себе бабезий.
Бабезии проникают в кровеносное русло и поселяются в эритроцитах, питаясь гемоглобином. Постоянно размножаясь простым делением, бабезии разрушают эритроцит и поселяются в другом, свободном эритроците.
Когда разрушаются эритроциты, в кровяное русло попадают продукты жизнедеятельности бабезий, и это вызывает интоксикацию организма собаки. Нарастает анемия из-за уменьшения здоровых, не зараженных эритроцитов и гипоксия в тканях. В почечных капиллярах свободный гемоглобин и клеточные оболочки разрушенных эритроцитов оседают, приводя к почечной недостаточности и появлению крови в моче. Иммунная система хозяина (собаки) разрушает больше эритроцитов, чем сама бабезия, пытаясь уничтожить «больные» клетки. Гемоглобин разрушается в печени, образуя билирубин. Организму приходится разрушать больше гемоглобина и, соответственно, больше билирубина образуется. Билирубин попадает в ткани и вызывает желтушное окрашивание слизистых оболочек и кожи животного.
Пироплазмоз (бабезиоз) собак – это сезонное протозойное гемолитическое заболевание, которое связано с активностью иксодовых клещей родов Dermacentor, Ixodes ricinus.
Иксодовые клещи начинают просыпаться с началом таяния снега и появлением проталин и уходят в спячку с появлением холодов. Просыпаются клещи при температуре воздуха +1…+3, а активными они будут уже при температуре воздуха +10 градусов Цельсия. Также большое значение играет влажность воздуха. Взрослые особи клещей могут ждать свою жертву (собаку, лису, волка) несколько лет (обычно не больше 2-х лет), зимуя каждый год. Напившиеся крови самки всегда зимуют, чтобы отложить яйца весной, сами же умирают.
Достаточно теплая и влажная осенняя погода в этом году привела к тому, что сезон значительно продлился и на момент написания статьи (начало ноября 2019 года) в клинике от пироплазмоза лечатся две собаки, и одна, к сожалению, погибла. Атипичное проявление заболевания, о чем будет речь ниже, привела к позднему обращению владельцев за помощью домашняя любимица погибла из-за тяжелого течения заболевания и развития летальных осложнений.
Атипичное проявление заболевания, о чем будет речь ниже, привела к позднему обращению владельцев за помощью домашняя любимица погибла из-за тяжелого течения заболевания и развития летальных осложнений.
Инкубационный период пироплазмоза зависит от возраста и сопутствующих заболеваний животного и варьирует от 2 дней до 3 недель. Данное заболевание может протекать в нескольких формах: сверхострой, острой, хронической и атипичной.
Классические клинические признаки пироплазмоза включают в себя вялость, отказ от корма, шаткость или неуверенность походки (заваливается задняя часть), моча становится коричневой, бурой или красной. Температура тела повышается до 40 и выше градусов при норме у собак от 37,5 до 39,0.
Хочется отметить, что в 2019 году в нашей клинике чаще встречались случаи с атипичным течением пироплазмоза. Клинические признаки при этом были очень разными, как правило стертыми и не настораживали владельцев. Температура тела находилась в пределах нормы. Не пропадал аппетит. Моча была чуть ярче (более желтая), чем обычно. У некоторых пациентов наблюдалось снижение активности, редко рвота (1-2 раза). У других собак с подтвержденным диагнозом владельцы отмечали несколько расслабленный стул без изменения цвета. У одного животного из клинических признаков была отмечена только слабость всех четырех конечностей и учащенное дыхание. Такие стертые клинические признаки приводят как к запоздалому обращению за ветеринарной помощью владельцев собак, так и отсутствию врачебной настороженности к протозойной причине заболевания, что приводит к запоздалой диагностике и развитию тяжелых, даже летальных осложнений и гибели собак.
Диагноз можно установить, учитывая факт снятия иксодового клеща с собаки и проявления клинических признаков. Диагноз всегда нужно подтверждать лабораторно! Для этого ветеринарный врач берет каплю периферической крови (из уха или когтя) собаки, делает мазок на предметном стекле. Далее это мазок окрашивается специальными красителями. При изучении под микроскопом врач находит бабезий в эритроцитах крови. Можно сдать венозную кровь в лабораторию, при этом в мазке из венозной крови содержание бабезий будет меньше, чем в мазке из периферической крови. Существуют и другие лабораторные методы определения наличия возбудителя в крови.
Далее это мазок окрашивается специальными красителями. При изучении под микроскопом врач находит бабезий в эритроцитах крови. Можно сдать венозную кровь в лабораторию, при этом в мазке из венозной крови содержание бабезий будет меньше, чем в мазке из периферической крови. Существуют и другие лабораторные методы определения наличия возбудителя в крови.
Всегда стоит брать, кроме мазка, общий клинический и биохимический анализы крови для того, чтобы понимать, насколько пострадал организм животного при заражении пироплазмозом, и назначить правильную терапию.
Обязательно вводится препарат для уничтожения бабезий. Он достаточно токсичный, но без него излечение невозможно! Применяются внутривенные инфузии для устранения обезвоживания и интоксикации. Иногда используются кортикостероиды и гепатопротекторы. Антибиотики обычно не назначают.
Лечение пироплазмоза должно проходить только в ветеринарной клинике! Только ветеринарный врач может правильно оценить состояние животного и назначить курс лечения в соответствии с клиническим состоянием питомца и данными анализов крови.
После переболевания пироплазмозом не вырабатывается иммунитет. Существуют вакцины от пироплазмоза, однако они обладают слабой эффективностью и не защищают от заболевания, а лишь снижают проявление клинических симптомов, что в некоторых случаях может затруднить диагностику.
Для этих целей на рынке представлен большой ассортимент инсектоакарицидных препаратов: ошейники, капли на холку, спреи, таблетки. При обработке животных этими препаратами всегда обращайте внимание на то, какой срок действия у каждого из них. Важно не пропускать обработки от клещей от начала марта до первых заморозков. Это значительно уменьшит риск заболевания пироплазмозом.
Ветеринарный врач-терапевт СВК «Свой Доктор», филиал Люблино г.Москва.
Семенова Мария Алексеевна
Бабезиоз — новые проблемы, решение в диагностике
ВВЕДЕНИЕ. Пироплазмоз собак (бабезиоз собак) является повсеместно распространенным протозойным заболеванием. Вызывается бабезиоз простейшими микроорганизмами Babesia spp, которые инокулируются в организм собаки или другого животного специфическими переносчиками – клещами.
У собак основыми переносчиками бабезиоза являются клещи рода Rhipicephalus, Dermatocentor или Haemaphysalis. На сегодняшний день по этиологическим агентам выделяют три формы бабезиоза собак (пироплазмоза собак).
Пироплазмоз (бабезиоз) собак является повсеместно распространенным протозойным заболеванием. Вызывается бабезиоз простейшими микроорганизмами Babesia spp, которые инокулируются в организм собаки или другого животного специфическими переносчиками – клещами. У собак основыми переносчиками бабезиоза являются клещи рода Rhipicephalus, Dermatocentor или Haemaphysalis. На сегодняшний день по этиологическим агентам выделяют три формы бабезиоза собак (пироплазмоза собак).
Первый вызывается B. canis и B. vogeli, вторая форма вызывается B. rossi, и третья B. gibsoni. Первая этиологическая форма бабезиоза является космополитической и широко распространенной в Европе и России. Вторая форма встречается в основном в Африке. Третья этиологическая форма считается эндемичной для Азии, Африки и Северной Америки. В то время как ее присутствие в Европе и России вызывает сомнение. Вместе с тем в России встречаются клинические формы бабезиоза, слабо поддающиеся терапии и носящие длительный ремитирующий характер. Этиологическая структура этих форм в России не исследовалась, вместе с тем многие зарубежные авторы утверждают, что без современной тонкой диагностики и установления видовой принадлежности бабезий невозможно осуществлять контроль за эффективностью терапии бабезиоза и назначать адекватное лечение.
Данная статья посвящена бабезиозу собак (пироплазмозу) с новым для РФ этиологическим агентом B. gibsoni.
gibsoni.
Семейство Babesiidae, Род Babesia и вид B. gibsoni.
Исторически сложилось так, что как бабезиоз человека, так и бабезиоз животных классифицировали на основании морфологии и размера паразита в эритроцитарных формах. При этом все малые бабезии собак, в какой то период начали называть Babesia gibsoni (17).
В последнее время были проведены генетические исследования малого бабезиоза собак, использую полимеразно-цепную реакцию (ПЦР). На основании генетических исследований было выделении три штамма Babesia gibsoni (Азия, азиатский), Babesia gibsoni (Калифорния, американский) и идентифицированная в 2000 на северо-западе Испании малая Babesia, о которой имеются сообщения и из Германии (Европейский штамм).
B. gibsoni – передаваемый клещом внутриклеточный гемопротозойный паразит диких и домашних собак (2,4,6,17). Первоначально данный возбудитель был выделен в Азии, но теперь его распространение подтверждено в Азии, Африке, Европе, Ближнем Востоке, Бразилии, Северной Америке (13, 15, 18, 19). Имеются сообщения о выделении данного возбудителя в Австралии. B. gibsoni (Азия) является местным штаммом в Шри-Ланке, Японии, Малайзии, Корее и Египте, позже, он был завезен на Средний Запад и Юго-восток Соединенных Штатов Америки и в Австралию. (1, 3, 5, 6). Его распространенность в полуостровных государствах Малайзии и Tайвани, составляет до 17 % от всех случаев заражения собак бабезиозом (2, 4, 6). В Японии в 1994 году этот процент был еще выше и доходил до 40 %. В таких странах как Япония, Tайвань и Соединенные Штаты Америки прослеживается четкая закономерность по предрасположенности к бабезиозу вызванному B. gibsoni таких пород собак как американский стаффордширский терьер и питбультерьер.
Штамм B. gibsoni (Калифорния) является местным в Калифорнии и генетически близок со штаммами, изолируемыми от диких животных, грызунов и людей в этом регионе (3, 10, 11, 12). Хотя о распространении бабезиоза вызванного Babesia volgeli в Австралии было известно давно, только в 2002 году Каппот сообщил о заражении 4-х собак породы американский питбультерьер, принадлежащих одному хозяину штаммом B. gibsoni (Азия) в пригороде Виктория (14). При этом никакой прямой связи с импортированными собаками не было найдено, предполагается, что найденный агент является местным штаммом.
gibsoni (Калифорния) является местным в Калифорнии и генетически близок со штаммами, изолируемыми от диких животных, грызунов и людей в этом регионе (3, 10, 11, 12). Хотя о распространении бабезиоза вызванного Babesia volgeli в Австралии было известно давно, только в 2002 году Каппот сообщил о заражении 4-х собак породы американский питбультерьер, принадлежащих одному хозяину штаммом B. gibsoni (Азия) в пригороде Виктория (14). При этом никакой прямой связи с импортированными собаками не было найдено, предполагается, что найденный агент является местным штаммом.
Таким образом, ареал распространения B. gibsoni постоянно расширяется, при этом специалисты это расширение связывают не с расширением ареала возбудителя как такового, а с улучшением диагностики и повсеместным внедрением ПЦР (1, 2, 3, 5, 8).
ПУТИ ПЕРЕДАЧИ ВОЗБУДИТЕЛЯОсновной вектор для B. gibsoni (Азия) в Индии и Шри-Ланке является клещ Haemaphysalis bispinosa, а также все его стадии развития, возбудитель может передаваться через несколько поколений клещей трансовариально.
В других сообщениях указана на то, что вектором B. gibsoni (Азия), в Индии является клещ Rhipicephalus sanguineus. B. gibsoni, как полагают, может передаваться не только взрослым клещом но и его личинками (нимфами). В Австралии вектором являются клещи H. longicornis и R. Sanguineus.
В то время как R. sanguineus широко распространен в Австралии, H. longicornis имеет распространение в Квинсленде, Новом Южном Уэльсе, Южной Австралии и Западной Австралия (16, 17, 19).
Естественный вектор клеща для B. gibsoni (Азия) в США не известен, но наиболее вероятно им являются клещи рода ixodid, которые питаются на собаках, такие как R. sanguineus и Dermacentor variabilis. Такие клещи как H. bispinosa и H. longicornis не встречаются в США.
bispinosa и H. longicornis не встречаются в США.
H. longicornis, как показывали, был способен к передаче B. gibsoni (Азия) и является вектором в Японии и Новой Зеландии. Он встречается главным образом в Северной части острова. Главными хозяевами H. longicornis в Новой Зеландии являются овцы, рогатый скот и олени, но эти клещи могут нападать на всех млекопитающих, включая собак и некоторых птиц (2,5, 12, 19)
Главный источник инфекции для собак — клещи переносчики (клещи, инфицированные мерозоитами бабезий, находящиеся в слюнных железах клеща). Клещи должны питаться на хозяевах в течение 2 — 3 дней прежде чем произойдет передача Babesia spp. (Kraje, 2001). Каждый из периодов кормления клеща на собаке длится приблизительно 4 — 7 дней. Периоды между кормлениями клеща от одной недели до нескольких месяцев. У наиболее резистентых собак вырабатываются антитела к бабезиям и после заражения, они клинически не заболевают, а остаются носителями бабезий, являясь основным источником и природным резервуаром возбудителя, от которого заражаются клещи. Особенно это характерно для диких плотоядных, таких как волки, шакал и бродячие собаки.
ПРЯМОЙ ПУТЬ ЗАРАЖЕНИЯ СОБАКПрямая передача возбудителя может произойти при переливании крови, содержащей B. gibsoni, через хирургические инструменты для таких процедур как купирование ушей и хвостов у щенков и молодых собак (как правило эти инструменты подвергаются меньшей обработке, а чаще одними и теми же инструментами выполняются манипуляции нескольким животным), а также при использовании неодноразовых шприцов.
Прямая передача может также произойти через укусы собак при драках, это предположение было высказано после сообщений о высокой предрасположенности питбультерьеров к бабезиозу, вызванному B. gibsoni., именно эти собаки чаще всего участвую в собачьих боях.
Имеются сообщения о трансплацентарной передачи B. gibsoni у собак (4, 6, 7). Проведены исследования о возможности передачи B. gibsoni через сперму, в результате которых было доказано, что данный путь не имеет эпизоотического значения (2, 3, 5).
ИНКУБАЦИОННЫЙ ПЕРИОДИмеются сообщиния о том, что преддоступный период (время от инфекции до появления B. gibsoni в крови) при заражении собак клещом H. longicornis был от 7 до 11 дней для собак. Инкубационный период (то есть время от заражения до начала клинических признаков), зависит от способа заражения и массивности инвазии, колеблется от 7 до 21 суток (2, 9).
КЛИНИЧЕСКИЕ ПРИЗНАКИ
Есть две клинические формы болезни, вызванной B. gibsoni. Острая форма, характеризующаяся лихорадкой, летаргией, гемолитической анемией и тромбоцитопенией (2, 3, 6, 7, 15, 17). Собаки, которые выздоравливают, даже при проведении эффективной терапии не освобождаются от возбудителя. У них развивается или хронический бабезиоз (вторая клиническая форма), или бессимптомное носительство возбудителя (3, 15, 17), при этом доказано хроническое течение бабезиоза по крайней мере в течение 38 месяцев (15).
При хроническом течении заболевания отмечается неустойчивая лихорадка, летаргия и потеря веса, данные признаки заболевания могут наблюдаться в течение нескольких лет.
Клинические признаки бабезиоза вызванного B. gibsoni являются очень разнообразными. В некоторых случаях болезнь протекает фульминантно с развитием синдрома полиорганных расстройств и смертью собаки, а в других заболевание никак себя не проявляет. Но общим для всех форм бабезиоза вызыванного B. gibsoni является персистенция возбудителя в организме и низкая эффективность почти всех терапевтический средств, что толкает ветеринарный врачей к полипрагмазии.
Имеются сообщения о том, что бабезиоз, вызванный B. gibsoni (Калифорния), более тяжелое заболевание, чем вызванный B. gibsoni (Азия) в Соединенных Штатах. В 6 из 15 случаев при естественном заражении собак B. gibsoni в Калифорнии, животные умерли или были подвергнуты эвтаназии из-за некурабельности заболевания (коэффициент смертности 40 %)(5, 8, 9).
Испанский (Европейский) штамм, при длительной персистенции вызывает выраженную регенеративную анемию и почечную недостаточность вследствие развития гломерулонефрита, что всегда приводит к гибели собак (5).
ОПАСНОСТЬ ДЛЯ ЧЕЛОВЕКАЗоонозныйпотенциал В. gibsoni сомнителен. Хотя в США многие случаи бабезиоза человека связаны с B. microti, который является ближайшим родственником В. gibsoni. Другой возбудитель бабезиоза человек B. divergens, вызывает бабезиоз в Европе также генетически сходен сВ. gibsoni.
Однако Persing с соавторами в 1995 сообщил о тяжелом заболевании людей, от которых удалось выделить B. gibsoni (Калифорнийский штамм), оба случая данного заболевания регистрировались у спленэктомированных пациентов. Этот же исследователь указывает на то, что у 16 % (8 из 51) людей, подвергшихся укусам клещей отмечались высокие титры антител к B. gibsoni.
КОНТРОЛЬ НАД КЛЕЩАМИ — ПРОФИЛАКТИКА БАБЕИЗОЗАНесмотря на то, что контроль над клещами очень полезен для профилактики бабезиоза у собак, тем не менее, эффективность всех существующих на сегодняшний день препаратов ограничена и не является абсолютной.
Фипронил (Fipronil, Merial) в настоящее времяявляется доступным и наиболее эффективным акарицидом для использования в ветеринарной практике у мелких домашних животных. Как сообщают производители препарат обладает более чем 90%-й эффективностью в контроле за клещами после 48 часов обработки (4, 5, 6). Было сообщение о том, что в клиническом испытании погибло более 90 % Ixodes holocyclus после обработки животного фипронилом, а через 72 часа животное полностью освободилось от клещей и эффект продлился 3недели. Таким образом, гибель клещей составила через 48 часов 96 %, а через 72 часа 100 %. (Atwell и другие, 1996).
Было сообщение о том, что в клиническом испытании погибло более 90 % Ixodes holocyclus после обработки животного фипронилом, а через 72 часа животное полностью освободилось от клещей и эффект продлился 3недели. Таким образом, гибель клещей составила через 48 часов 96 %, а через 72 часа 100 %. (Atwell и другие, 1996).
Однако клещи быстро адаптируются и приобретают разистентность даже к очень эффективным препаратам, так есть сообщение из Австралии, об обнаружении клещей на собаках обработанных фипронилом.
Появляются новые рекомендации от ветеринарных специалистов о ежемесячной обработке собак фипронилом против клещей, а в ряде случаев есть рекомендации об обработке собак каждые две недели.
На сегодняшний день появляются новые средства в контроле над клещами. Скалибор инсекто-акарицидный ошейник (Scalibor Protector Band) — противопаразитарное лекарственное средство для уничтожения насекомых и иксодовых клещей, паразитирующих на собаках, и защиты животных от их нападения. Скалибор инсекто-акарицидный ошейник содержит в качестве действующего вещества дельтаметрин – 4 % (в весовом отношении). Дельтаметрин ((S)-циано(3-феноксифенил) метил (1R, 3R)-3-(2,2-дибромвинил)-2,2-диметилциклопропанкарбоксилат), входящий в состав ошейника, постепенно выделяясь с поверхности ленты, переносится на кожно-волосяной покров животного и оказывает инсекто-акарицидное (контактное и кишечное) и репеллентное действие на насекомых (блох, вшей, власоедов, комаров, москитов) и иксодовых клещей, паразитирующих на собаках. Механизм действия дельтаметрина заключается в необратимой активации натриевых каналов мембран нервных клеток, деполяризации клеточных мембран и блокаде нервной проводимости, что приводит к нарушению двигательных рефлексов, и в конечном итоге вызывает полный паралич и гибель членистоногих. Обладая высокой липофильностью, дельтаметрин, практически не всасываясь, распределяется по поверхности кожи и обеспечивает длительную защиту животного от эктопаразитов.
Непрерывное использование Скалибор инсекто-акарицидного ошейника обеспечивает защиту животного от иксодовых клещей в течение 5-6 месяцев, но надо помнить что максимальный защитный эффект достигается через неделю после начала использования ошейника, то есть одевать ошейник на животное надо за 7 дней до предполагаемых прогулок на природе.
Хозяева животных и ветеринарные специалисты должны помнить, что нет 100% эффективных средств в контроле над иксодовыми клещами у собак, а следовательно нам всем приходится рано или поздно сталкиваться с бабезиозом.
ДИАГОСТИКАНаиболее простым и убедительным способом диагностики бабезиоза является его обнаружение в мазках крови при световой микроскопии. Однако, обнаружение паразитов Babesia spp является трудной задачей у собак с неочевидными или хроническими инвазиями, так как уровень паразитемии у таких животных очень низок. Кроме того, световой микроскопией невозможно убедительно идентифицировать различные виды бабезий. Поэтому, ветеринарные специалисты длительное время нуждались в эффективных диагностических тестах для обнаружения бабезий и в частности B. gibsoni.
В последнее время стало возможно обнаружить B. gibsoni в крови собак методом ПЦР. ПЦР имеет такие преимущества как, высокая степень чувствительности и специфики. Внедрение быстрых и простых тестов на диагноз бабезиоз вызванный B. gibsoni требуется в Российской федерации, где подобных исследований не проводилось. Однако внедрению этих методом мешает низкая информативность в первую очередь ветеринарных врачей в отношении особенностей бабезиоза вызванного B. gibsoni и самих владельцев животных, которые могли бы самостоятельно обращаться за диагностикой в специализированные диагностические центры (http://www.vetlabcentr.ru). В данной статье мы сообщается о случае бабезиоза вызванного Babesia gibsoni в Ростовской области.
КЛИНИЧЕСКИЙ СЛУЧАЙ
Зимой 11. 02.2011 года в ветеринарную клинику «Вита» г. Шахты поступила собака, кобель 3-х летнего возраста породы американский стаффордширский терьер. У животного отмечался неустойчивый аппетит, периодическая слабость и бледность слизистых оболочек. Со слов хозяев приступы слабости у собаки отмечались в течение года (с апреля 2010 г). После самостоятельных кратковременных курсов лечения доксициклином в дозе 200 мг 1 раз в день задаваемый внутрь в течение от 1 до 5 дней у собаки наступала ремиссия, которая длилась от 5 дней до 1 месяца. У нее отмечалось улучшение аппетита, розовели слизистые оболочки, она становилась активнее. Специфической терапии бабезиоза в весенне-летний период 2010 года не проводилось.
02.2011 года в ветеринарную клинику «Вита» г. Шахты поступила собака, кобель 3-х летнего возраста породы американский стаффордширский терьер. У животного отмечался неустойчивый аппетит, периодическая слабость и бледность слизистых оболочек. Со слов хозяев приступы слабости у собаки отмечались в течение года (с апреля 2010 г). После самостоятельных кратковременных курсов лечения доксициклином в дозе 200 мг 1 раз в день задаваемый внутрь в течение от 1 до 5 дней у собаки наступала ремиссия, которая длилась от 5 дней до 1 месяца. У нее отмечалось улучшение аппетита, розовели слизистые оболочки, она становилась активнее. Специфической терапии бабезиоза в весенне-летний период 2010 года не проводилось.
При клиническом осмотре на день поступления животного отмечалась гипертермия (40,1 °C) и бледные слизистые оболочки. У животного была отобрана кровь для лабораторного исследования. Кровь у животного исследовали в день поступления, в процессе лечения и на 30 день от начала лечения.
Результаты морфологических исследований крови, выявил у животного гиперхромную анемию (3,25?1012/л эритроцитов), нейтрофильный лейкоцитоз (13,34?109/л лейкоцитов), тромбоцитопению (42,31?109/л тромбоцитов), одновременно наблюдалось повышение СОЭ до 44, 87 мм/час (табл. 1, кол. 2).
Таблица 1
Морфологические показатели крови у исследуемой собаки, кобель 3 года
| Показатели |
Дни лечения |
|||
|
1 |
7 |
14 |
30 |
|
|
1 |
2 |
3 |
4 |
5 |
|
Гемоглобин, г/л |
88,87 |
99,89 |
105,41 |
138,22 |
|
Эритроциты, ?1012/л |
3,25 |
5,01 |
5,26 |
6,48 |
|
Гематокрит |
0,29 |
0,37 |
0,41 |
0,44 |
|
Лейкоциты, ?109/л |
13,34 |
11,22 |
10,71 |
9,68 |
|
Тромбоциты, ?109/л |
42,31 |
114,25 |
256,98 |
247,45 |
|
СОЭ, мм/час |
44,87 |
21,13 |
7,45 |
3,21 |
При проведении биохимических исследований крови кроме незначительного повышения печеночных трансфераз и щелочной фосфатазы никаких других отклонений не отмечалось (табл. 2, кол. 2).
2, кол. 2).
Одним из предполагаемых диагнозов после морфологических и биохимических исследований крови был бабезиоз (пироплазмоз). В пользу этого заболевания говорила гипертермия, гиперхромная анемия и тромбоцитопения.
Конец достаточно суровой зимы 2011 года исключал нападение клещей на собаку, однако мы решили проверить собаку на бабезиоз и отправили кровь для исследования в реакции ПЦР в «Центр диагностики болезней животных» (http://www.vetlabcentr.ru), поскольку исследования мазков крови в световой микроскопии, проведенные в клинике не дали положительных результатов.
Таблица 2
Биохимические показатели крови у исследуемой собаки, кобель 3 года
| Показатели |
Дни лечения |
|||
|
1 |
7 |
14 |
30 |
|
|
1 |
2 |
3 |
4 |
5 |
|
Аланинаминотрансфераза, Е/л |
101,45 |
95,56 |
121,39 |
89,13 |
|
Щелочная фосфатаза, Е/л |
109,6 |
87,47 |
91,34 |
65,27 |
|
Мочевина, ммоль/л |
11,25 |
14,28 |
9,42 |
7,31 |
|
Билирубин, мкмоль/л |
8,8 |
7,43 |
8,45 |
8,99 |
|
Глюкоза, ммоль/л |
4,25 |
5,11 |
4,99 |
4,75 |
|
Общий белок, г/л |
64,2 |
65,5 |
67,58 |
74,31 |
|
Альбумин, г/л |
23,23 |
24,41 |
27,22 |
29,34 |
В диагностическом центре исследования на бабезиоз были проведены методом ПЦР. В первый же день из пробы крови была выделена ДНК Babesiaspp (то есть общий бабезиоз). Результаты ПЦР теста оказались положительными (рис. 1).
Рисунок 1. Выявление ДНК Babesiaspp методом ПЦР
с гибридизационно-флуоресцентной детекцией в режиме реального времени
Таблица 3
Результаты ПЦР теста у исследуемой собаки, кобель 3 года
| № | Имя | Тип | Ct |
| 1 | К- | Отрицательный. контроль | |
| 2 | №1 (желтый) | Образец в день поступления животного | 12,51 |
| 3 | №2 (фиолетовый) | Образец на 7 день лечения | 13,10 |
| 4 | №3 (розовый) | Образец на 30 день наблюдения | отр |
| 5 | Здоровая собака | Образец | отр |
| 6 | К+ (зеленый) | Положительный контроль | 14,26 |
Учитывая необычность клинической картины (хроническое, вялое течение), зимний период в которой возникла инвазия, длительное течение и реметирующий характер заболевания в «Диагностическом центре» провели дальнейшую идентификацию возбудителя вызвавшего бабезиоз (пироплазмоз) у исследуемого животного.
Были проведены исследование на выявление ДНК Babesia canis методом ПЦР с гибридизационно-флуоресцентной детекцией в режиме реального времени, при этом был получен отрицательный результат. Надо сказать, что на этом этапе исследования полученные результаты оказались для нас несколько неожиданными, и мы проверили образцы крови от исследуемой собаки на присутствие ДНК Babesia gibsoni и получили положительный результат (рис. 2). Таким образом, в центре диагностики у исследуемой собаки был поставлен диагноз на бабезиоз, вызванный Babesia gibsoni.
На основании диагноза поставленного в диагностическом центре нами был назначен курс терапии. Собак получила Diminazene aceturate (диминазина ацетурат, беренил, азидин) в дозе 5,0 мг/кг массы животного однократно. Через 7 и 14 дней после введения препарата были проведены морфологические и биохимические исследования крови. Результаты представлены в таблицах 1, 2 (колонки 3,4). Как видно отмечалась незначительная положительная динамика по показателям красной крови, несколько снизился лейкоцитоз. Однако при биохимическом исследовании отмечался вираж аланинаминотрансферазы. Клинически отмечалось улучшение состояния животного, оно стало подвижнее, слизистые стали розовее.
Были проведены повторные исследования в реакции ПЦР ни 14 день после введения диминазина и получен положительный результат (рис. 2).
1 – образец крови до лечения;
2, 3 – образец крови после проведения первого курса лечения;
Рисунок 2. Выявление ДНК Babesia gibsoni методом ПЦР
с электрофоретической детекцией продукции амплификации в агарозном геле
Учитывая длительное рецидивирующее течение заболевания было принято решение продолжит терапию по протоколу: Diminazene aceturate (диминазина ацетурат, беренил, азидин) в дозе 10,0 мг/кг массы животного дважды с интервалом в 14 дней, клиндамицин, метронидазол (15 мг/кг каждые 12 часов), доксициклин (5 мг/кг каждые 12 часов) в течении 10 дней.
На 30 день от начала терапии был проведены морфологические исследования крови, результаты представлены в таблицах 1,2 (колонки 5).
В третий раз проведены исследования в ПЦР для выявления ДНК Babesia gibsoni, получен отрицательный результат. За животным проводится наблюдение. На 15 марта 2011 года состояние животного удовлетворительное, результаты ПЦР теста на Babesia sppи Babesia gibsoni отрицательны.
ЗАКЛЮЧЕНИЕ
Нашими исследованиями показана высокая вероятность наличия Babesia gibsoni в паразитофауне Ростовской области. Трудно установить каким путем данный возбудитель попал на территорию Ростовской области, и был ил он на данной территории раньше. Наши исследования историй болезни показали, что на территории Ростовской области довольно часто встречаются собаки с диагнозом аутоиммунных гемолитических анемий. Практически во всех этих случаях проводилось пробное лечение бабезиоза, хотя бабезии в мазках крови врачами не обнаруживались. После такого отрицательного результата в диагностике и терапии, врачи, как правило, лечили анемии симптоматически, в том числе и с применением кортикостероидов. В ряде случаев такая терапия приводила к успеху, но в 80% заканчивалась летально. Такой ретроспективный анализ позволяет нам утверждать, что во всех случаях после терапии тяжелого бабезиоза, во всех случаях рецидивирующих и упорно протекающих анемий неизвестной этиологии необходимо проводить диагностику в ПЦР на ДНК возбудителей бабезиоза, в том числе и Babesia gibsoni. Своевременная диагностика в ПЦР позволяет не только правильно ставить диагнозы на бабезиоз в диагностически сложных случаях, но и проводить контроль эффективности терапии, поскольку не всегда однократный противобабезиозный курс бывает эффективным даже при бабезиозе вызванном Babesia canis.
P.S.
Бебезиоз на сегодняшний день ставит перед ветеринарными специалистами все более сложные задачи и без современной диагностики с выявлением ДНК возбудителей решать эти задачи чрезвычайно сложно.
ЛИТЕРАТУРА
- Anderson JF, Magnarelli LA, Sulzer AJ (1980). Canine babesiosis: Indirect fluorescent antibody test for a North American isolate of Babesia gibsoni. American Journal of Veterinary Research,41: 2102-2105.
- Beban H (2003). Absence of Babesia gibsoni in New Zealand dogs. Surveillance 30(1), in press,March 2003.
- Birkenheuer AJ, Levy MG, Savary KCM et al (1999). Babesia gibsoni infections in dogs from North Carolina. Journal of the American Animal Hospital Association, 35: 125-128.
- Camacho AT, Pallas E, Gestal JJ, Guitian FJ, Olmeda AS, Goethert HK, Telford SR (2001). Infection of dogs in northwest Spain with a Babesia microti-like agent. The Veterinary Record,149, 552-555.
- Chang GN, Tu CH (1992). A serological survey of canine babesiosis in Taiwan. Journal of the Chinese Society of Veterinary Science, 18: 125-131.
- Heath ACG (2001). Exotic tick interceptions 1980-2000. Surveillance 28(4): 13-15.
- Kjemtrup AM, Kocan AA, Whitworth L, Meinkoth J, Birkenheuer AJ, Cummings J, Boudreaux MK, Stockham SL, Irizarry-Rovira A, Conrad PA (2000). There are at least three genetically distinct small piroplasms of dogs. International Journal for Parasitology, 30, 1501-1505.
- Kocan A, Kjemtrup A, Meinkoth J, Whitworth LC, Murphy GL, Decker L, Lorenz M (2001). A genotypically unique Babesia gibsoni-like parasite recovered from a dog in Oklahoma. Journal of Parasitology, 87: 437-438.
- Kraje AC (2001). Canine haemobartonellosis and babesiosis. Compendium of Continuing Education for the Practicing Veterinarian, 23:4, 310-318.
- Macintire DK, Boudreaux MK, West GD, Bourne C, Wright JC, Conrad PA (2002).
 Babesia gibsoni infection among dogs in the southeastern United States. Journal of the American Veterinary Medical Association, 220: 325-329.
Babesia gibsoni infection among dogs in the southeastern United States. Journal of the American Veterinary Medical Association, 220: 325-329. - Meinkoth JH, Kocan AA, Loud SD, Lorenz MD (2002). Clinical and hematologic effects of experimental infection of dogs with recently identified Babesia gibsoni isolates from Oklahoma. Journal of the American Veterinary Medical Association, 220: 185-189.
- OIE (2002). International Animal Health Code. Office International des Epizooties, Paris.
- Onishi T, Nakai M, Goto A, Horie M, Nakata E, Kajikawa T (1994). Prevalence of canine babesiosis due to Babesia gibsoni in Japan. Journal of the Japan Veterinary Medical Association, 47: 23-28.
- Perkins SCB (2000). Babesia and the Pet Travel Scheme, The Veterinary Record, 147: 460.
- Persing DH, Herwaldt BL, Glaser C, Lane RS, Thomford JW, Mathiesen D, Krause PJ, Phillip DF, Conrad PA (1995). Infection with a babesial-like organism in northern California. New England Journal of Medicine, 332: 298-303.
- Yamane I, Conrad PA, Gardner I (1993). Babesia gibsoni infections in dogs. Journal of Protozoology Research, 3: 111-125.
- Yamane I, Thomford JW, Gardner IA, Dubey JP, Levy M, Conrad PA (1993). Evaluation of the indirect fluorescent antibody test for diagnosis of Babesia gibsoni infections in dogs. American Journal of Veterinary Research, 54: 1579-1584.
- Yamane I, Gardner IA, Ryan CP, Levy M, Urrico J, Conrad PA (1994). Serosurvey of Babesia canis, Babesia gibsoni and Ehrlichia canis in pound dogs in California, USA. Preventive Veterinary Medicine, 18: 293-304.
- Zahler M, Rinder H, Schein E, Gothe R (2000). Detection of a new pathogenic Babesia microtilike species in dogs. Veterinary Parasitology, 89: 241-248.
Пироплазмоз, бабезиоз, собаку укусил клещ, лечение
Пироплазмоз, бабезиоз, собаку укусил клещ, лечение
- Подробности
- Просмотров: 8972
Пироплазмоз (бабезиоз), или ВНИМАНИЕ, КЛЕЩИ!
Диагностика и лечение пироплазмоза.
С наступлением теплых деньков хозяева с домашними животными выезжают на природу.
Но одновременно с этим наступает время, когда активизируются разнообразные насекомые. Среди них так же встречаются переносчики разнообразных заболеваний.
Собаку укусил клещ! Что делать? Возможно, Ваша собака больна пироплазмозом!
Например, клещи, которые являются кровососущими насекомыми и переносчиками заболевания ПИРОПЛАЗМОЗ (бабезиоз).
Клещи встречаются не только в лесах, но и в городах. Они наиболее активны в весенне-осенний период времени, когда температура окружающей среды наиболее благоприятна. В жаркие летние дни клещи встречаются в тенистых прохладных лесах.
Пироплазмоз — это заразное заболевание, возбудитель которого селится в кровяных клетках организма и разрушает кровь (эритроциты), в результате кровь теряет свои функции и зачастую без лечения животное может погибнуть.
Когда клещ кусает животное, с его слюной в кровь попадает возбудитель заболевания.
Нужно иметь в виду, что не каждый клещ может быть заразен, и если это так, тогда особого вреда животному не причиняется.
Но если животное кусает клещ, в слюне которого находится возбудитель, то животное заболевает.
Инкубационный период заболевания может длиться от нескольких дней до трёх недель.
Клинические признаки пироплазмоза (бабезиоза).
Начало острого течения заболевания характеризуется повышением температуры до 41-42 градусов Цельсия, отказом от еды, некоторые собаки пьют много воды (жажда), животное становится вялым, учащается дыхание и пульс, слабеют задние конечности и от этого у крупных собак появляется шаткая походка. На 2-3 день моча меняет цвет от ярко-красного до цвета тёмного пива, а видимые слизистые становятся бледными и при отсутствии своевременного лечения – приобретают жёлтый оттенок (гемолитическая желтуха). В редких случаях наблюдается кровавый кал, кровотечение на слизистых, язвенный стоматит, нервные явления.
В редких случаях наблюдается кровавый кал, кровотечение на слизистых, язвенный стоматит, нервные явления.
Заболевание проходит с сильной интоксикацией, поэтому сильно страдают печень, почки, сердце.
При отсутствии своевременного лечения большой процент животных погибает, а те, которые выживают, — страдают болезнями внутренних органов.
Диагностика пироплазмоза
Для подтверждения диагноза Пироплазмоз в лабортории ветеринарной клиники Котофей проводят анализ крови методом микроскопии на предмет возбудителя заболевания — babesia canis. В поле зрения микроскопа в этом случае наблюдается характерная картина разрушающейся крови. Дополнительно так же делается общий анализ мочи, подтверждающий заболевание.
Лечение пироплазмоза.
Лечение пироплазмоза включает в себя капельницы (инфузии) и введение препаратов, направленных на уничтожение возбудителя заболевания и препаратов, профилактирующих обострение заболеваний внутренних органов, таких как печень.
Для профилактики пироплазмоза применяют препараты, отпугивающие или уничтожающие насекомых-переносчиков.
В клинике Котофей всегда в наличии имеются необходимые препараты для лечения и профилактики пироплазмоза.
В качестве иллюстраций посмотрим фотографии:
1. Клещ средних размеров, снятый с собаки, в масштабе со спичкой.
2. Несколько клещей, снятых с одной собаки в клинике Котофей. К счастью, ни один из них не оказался носителем пироплазмоза! Собака не заболела.
Такое везение бывает чрезвычайно редко!
P.S. Все права на статью и фотоматериалы — защищены. Перепечатка разрешается только при условии ссылки на этот сайт и эту статью.
Как лечить инфекцию бабезии у собак
Инфекции бабезии встречаются у собак и других видов и передаются в основном клещами. Тяжесть болезни значительно варьируется в зависимости от вида бабезии, а также от иммунного ответа инфицированной собаки. Первичным результатом инфекции бабезии является анемия, поскольку иммунная система разрушает инфицированные эритроциты, но бабезия может оказывать и другие эффекты на весь организм.
Первичным результатом инфекции бабезии является анемия, поскольку иммунная система разрушает инфицированные эритроциты, но бабезия может оказывать и другие эффекты на весь организм.
Что такое бабезия?
Бабезия — это тип протозойного паразита, который поражает эритроциты, вызывая заболевание, называемое бабезиозом.Существует множество штаммов бабезии, поражающих множество животных, но лишь несколько штаммов поражают собак. Поскольку понимание бабезии все еще улучшается, диагностика и лечение инфекций бабезии остаются сложной задачей.
Признаки и симптомы бабезии у собак
Инфекции Babesia имеют широкий диапазон степени тяжести: они могут быть очень легкими или очень тяжелыми, иногда даже смертельными. Степень тяжести зависит в основном от штамма Babesia, вызывающего заболевание, но также и от иммунной системы собаки.Штаммы бабезии в США обычно вызывают более легкое заболевание по сравнению с некоторыми штаммами, обнаруженными в других местах. Течение болезни может быть циклическим, с периодами симптомов, перемежающимися временами, когда симптомы отсутствуют.
Признаки бабезии у собак
- Лихорадка
- Слабость
- Летаргия
- Бледность десен и языка
- Красная или оранжевая моча
- Желтуха (желтый оттенок кожи, десен и белков глаз)
- Увеличенные лимфатические узлы
- Увеличенная селезенка
В тяжелых случаях также могут быть поражены многие системы органов, включая легкие, желудочно-кишечный тракт, почки и нервную систему.Иногда собаки страдают очень острой формой бабезиоза, внезапно впадают в шок и теряют сознание.
Причины бабезии
Большинство инфекций бабезии передаются через клещей. Поскольку она распространяется клещами, бабезия чаще всего встречается в теплую погоду, когда клещи наиболее многочисленны. Инфекции также возможны при переливании крови, и в случае одного штамма Babesia ( Babesia gibsoni ) передача от собаки к собаке через укушенные раны считается способом передачи. Мать также может передать бабезию своим детенышам до рождения. В то время как любая собака может быть инфицирована, молодые собаки, как правило, болеют более серьезными заболеваниями. Грейхаунды, питбультерьеры и американские стаффордширские терьеры кажутся наиболее восприимчивыми к инфекции.
Мать также может передать бабезию своим детенышам до рождения. В то время как любая собака может быть инфицирована, молодые собаки, как правило, болеют более серьезными заболеваниями. Грейхаунды, питбультерьеры и американские стаффордширские терьеры кажутся наиболее восприимчивыми к инфекции.
Диагностика Бабезии
Подтвердить диагноз бабезиоза может быть сложно. Анализы крови могут показать снижение количества эритроцитов и тромбоцитов (тромбоцитопения), но это не характерно для бабезии. Мазки крови могут быть исследованы на наличие микроорганизмов Babesia.Если они присутствуют, диагноз можно подтвердить, но они не всегда могут быть обнаружены на мазке. Взятие крови из пореза на кончике уха или ногтя на ноге может повысить шансы на обнаружение паразитов.
Кровь также можно проверить на антитела к бабезии, хотя иногда это может привести к ошибочным результатам. Специализированное тестирование может проверять генетический материал из Бабезии, и хотя это самый чувствительный тест, он не является широко доступным и также имеет некоторые ограничения. Как правило, для постановки диагноза используется комбинация лабораторных тестов, клинических признаков и истории болезни.Диагноз еще больше усложняется тем фактом, что собаки, инфицированные бабезией, также могут быть инфицированы другими заболеваниями, переносимыми клещами, такими как Эрлихия, болезнь Лайма или пятнистая лихорадка Скалистых гор.
Лечение
Для лечения бабезии использовались различные лекарства с переменным успехом. Имидокарб дипропионат чаще всего используется в США; диминазена ацетурат недоступен в США, но используется как вариант лечения в других странах. Оба имеют ряд побочных эффектов, которые могут быть довольно серьезными.Новая комбинация препаратов, включая азитромицин и атоваквон, является многообещающей, хотя и дорогой. В тяжелых случаях может потребоваться переливание крови.
Лечение снимает симптомы бабезиоза, но кажется, что во многих случаях оно не полностью выводит паразита из организма. Собаки могут оставаться инфицированными на низком уровне, а бабезия может снова обостриться во время стресса или снижения иммунной функции. Собак, у которых была диагностирована бабезия, нельзя разводить или использовать в качестве доноров крови (для предотвращения распространения болезни).
Собаки могут оставаться инфицированными на низком уровне, а бабезия может снова обостриться во время стресса или снижения иммунной функции. Собак, у которых была диагностирована бабезия, нельзя разводить или использовать в качестве доноров крови (для предотвращения распространения болезни).
Как предотвратить бабезию
Предотвращение контакта с клещами, являющимися переносчиками бабезии, является лучшим средством предотвращения бабезиоза. Ежедневно проверяйте свою собаку на наличие клещей и удаляйте их как можно скорее (клещи должны питаться не менее 24–48 часов, чтобы распространить бабезию). Это особенно важно в пик сезона клещей или если ваша собака проводит время в лесу или в высокой траве (избегайте этих мест в сезон клещей).
Продукты, предотвращающие появление клещей, такие как ежемесячные средства защиты от паразитов (например,g., Frontline, Revolution) или противоклещевые ошейники (например, Preventic); обязательно следуйте советам ветеринара при использовании этих продуктов. Подстригайте во дворе траву и кусты. В районах, где клещи представляют собой серьезную проблему, вы также можете подумать о том, чтобы обработать двор и территорию вольера от клещей. Вакцина доступна в Европе, но она эффективна только против определенных штаммов бабезии, и даже в этом случае она не эффективна на 100 процентов.
Если вы подозреваете, что ваш питомец болен, немедленно вызовите ветеринара.По вопросам, связанным со здоровьем, всегда консультируйтесь со своим ветеринаром, так как он осмотрел вашего питомца, знает историю его здоровья и может дать наилучшие рекомендации для вашего питомца.
Совет по паразитам животных-компаньонов | Babesia spp.
Виды
Собачий
Babesia canis vogeli
Babesia sp. (Коко; также известный как большой Babesia sp.)
Babesia vulpes (также известна как B.microti -like, Babesia ср. microti , B. annae и Theileria annae )
microti , B. annae и Theileria annae )
Babesia gibsoni
Babesia conradae
- Инфекции Babesia у домашних собак включают более крупные пироплазмы, в совокупности описываемые как B. canis , и более мелкие пироплазмы, которые часто описываются как B. gibsoni -подобные. Три подвида B. canis , B. canis canis , B.canis vogeli и B. canis rossi , дифференцируются на основе патологии, антигенных свойств, клещевых переносчиков и генетической характеристики, и эти паразиты все чаще признаются как отдельные виды в современной литературе. Babesia canis vogeli (или B. vogeli ) является энзоотическим для США. Babesia sp. (Коко) — крупный вид, связанный с сообщениями о случаях заболевания в Иллинойсе, Северной Каролине, Нью-Джерси, Нью-Йорке, Техасе и Оклахоме, США. Babesia vulpes — небольшой вид, первоначально описанный на севере Испании, который встречается у диких псовых и редко домашних собак. Он присутствует в других европейских странах и в Северной Америке. Babesia conradae — это небольшой вид, который был обнаружен только у собак в Калифорнии с историей иммуносупрессии.
Кошачьи
Babesia spp. инфекций у домашних кошек в США не зарегистрировано.
Обзор жизненного цикла
- Собаки заражаются Babesia spp. при заражении спорозоитами в слюне клещей. После инокуляции спорозоитов Babesia вторгаются в эритроциты, где они размножаются бесполым путем путем бинарного деления. Образующиеся мерозоиты разрывают эритроциты и продолжают вторгаться в дополнительные эритроциты. Род Babesia отличается от других родов гемоспоридий наличием внутриэритроцитарных пироплазм только у позвоночных-хозяев.
- После проглатывания клещом Babesia подвергается бесполому делению с последующим развитием гамет (гамогония).
 Гамогония сопровождается бесполым размножением, в результате чего в слюнных железах клещей образуются многочисленные спорозоиты. Спорозоиты — это стадии, которые являются инфекционными для позвоночных-хозяев. Ниже приведены этапы жизненного цикла. Пироплазмы находятся в позвоночном хозяине. Все остальные этапы отмечены галочкой.
Гамогония сопровождается бесполым размножением, в результате чего в слюнных железах клещей образуются многочисленные спорозоиты. Спорозоиты — это стадии, которые являются инфекционными для позвоночных-хозяев. Ниже приведены этапы жизненного цикла. Пироплазмы находятся в позвоночном хозяине. Все остальные этапы отмечены галочкой.
Внутриэритороцитарные пироплазмы (репликация) -> гаметы -> сливаются с образованием зиготы -> мигрируют в гемоцель (подвергаются мейозу) -> оокинеты -> спорокинеты -> спорозоит
- Babesia canis vogeli , как полагают, в основном передвигается между домашними собаками и Rhipicephalus sanguineus , коричневым собачьим клещом.
- Babesia gibsoni и другие мелкие виды также считаются переносчиками R. sanguineus ; хотя их жизненные циклы еще не подтверждены.
- Ятрогенная передача также возможна при переливании крови или зараженных кровью фомитах.
- Драка между собаками — вероятный способ передачи инфекции B. gibsoni это может частично объяснить относительно высокую распространенность инфекции среди американских стаффордширских и американских питбультерьеров.
- Переносчики других видов Babesi a в настоящее время неизвестны.
Бабезиоз | Клещевые болезни | CVBD
Продолжительность инкубации сильно варьируется, обычно 1-3 недели, в зависимости от вида возбудителя, но иногда может быть намного короче. Заболевание собак начинается с лихорадки, за которой следует снижение потребления пищи, потеря веса, анемия, тромбоцитопения, спленомегалия, довольно часто желтуха и наиболее характерный цвет мочи, который становится коричневым из-за гемоглобинурии.Могут наблюдаться и другие признаки, включая рвоту, обморок (обморок), отек, асцит, кровотечение на коже и слизистой оболочке, а также различные другие симптомы, вплоть до нарушений центральной нервной системы (т.е. Babesia rossi ). В случае Babesia canis и Babesia gibsoni может развиться прогрессирующая гемолитическая анемия, в то время как B. rossi может даже включать гипоксический, гипотензивный шок с диссеминированным внутрисосудистым свертыванием (ДВС), синдром системного воспалительного ответа и полиорганную дисфункцию. синдром (СПОСОБ).
rossi может даже включать гипоксический, гипотензивный шок с диссеминированным внутрисосудистым свертыванием (ДВС), синдром системного воспалительного ответа и полиорганную дисфункцию. синдром (СПОСОБ).
Помимо описанных выше острых форм, бабезиоз собак довольно часто проявляется как хроническая инфекция с умеренной гипертермией, потерей веса, летаргией, легочными или почечными заболеваниями. В энзоотических областях, где многие собаки повторно заражаются, болезнь может быть обнаружена у собак, у которых наблюдается только снижение активности и анорексия.
Выздоравливающие животные обычно становятся хроническими (от месяцев до, возможно, на всю жизнь) носителями Babesia sp., Даже после лечения. Хотя эти животные выглядят здоровыми, если не подвергаются стрессу, они являются резервуаром инфекции для восприимчивых животных и имеют неоптимальные спортивные результаты.Они представляют опасность при использовании в качестве доноров крови.
В отличие от бабезиоза у других домашних животных бабезиоз кошек не связан с гипертермией (Futter & Belonje, 1980). Болезнь у кошек, как правило, протекает без лихорадки, является хронической субфебрильной болезнью. Наиболее частыми симптомами являются анорексия, вялость и анемия, за которыми следует желтуха (Schoeman et al., 2001). Менее распространенными признаками являются слабость, запор и пика (Schoeman et al., 2001). Паразитемия варьируется от очень низкой до очень высокой.Лабораторные исследования обычно включают регенеративную анемию, повышение уровня аланинтрансаминазы (но не щелочной фосфатазы) и общего билирубина, а также различные нарушения электролитного баланса. Количество тромбоцитов варьирует, а тромбоцитопения — противоречивый результат. Иногда может наблюдаться вторичная иммуноопосредованная гемолитическая анемия. Большинство пораженных кошек, по-видимому, относятся к молодым людям в возрасте до трех лет (Schoeman et al., 2001).
Клинические проявления бабезиоза собак могут осложняться сочетанной инфекцией с другими возбудителями клещевых инфекций. Чаще всего возникает коинфекция Ehrlichia canis , поскольку оба патогена имеют общий переносчик Rhipicephalus sanguineus . Собаки, коинфицированные этими двумя организмами, с большей вероятностью могут иметь гемолитическую анемию, осложненную кровотечением, вторичным по отношению к тромбоцитопении, которая возникает при моноцитарном эрлихиозе собак (CME). Были зарегистрированы сочетанные инфекции с другими возбудителями, передаваемыми членистоногими, например с бактериями рода Bartonella и Rickettsia .
Чаще всего возникает коинфекция Ehrlichia canis , поскольку оба патогена имеют общий переносчик Rhipicephalus sanguineus . Собаки, коинфицированные этими двумя организмами, с большей вероятностью могут иметь гемолитическую анемию, осложненную кровотечением, вторичным по отношению к тромбоцитопении, которая возникает при моноцитарном эрлихиозе собак (CME). Были зарегистрированы сочетанные инфекции с другими возбудителями, передаваемыми членистоногими, например с бактериями рода Bartonella и Rickettsia .
Как и у собак, сопутствующие инфекции кошек (например, Mycoplasma haemofelis , вирус лейкемии кошек [FeLV], вирус иммунодефицита кошек [FIV]) могут вносить вклад в клиническую картину.
Babesia gibsoni • MSPCA-Angell
Шон Кернс, DVM, DACVIM
angell.org/internalmedicine
[email protected]
617-541-5186
Babesia gibsoni — одно из нескольких новых инфекционных заболеваний в Соединенных Штатах.Задокументировано несколько генотипов, но наиболее распространенным в Соединенных Штатах является азиатский генотип, которому и будет посвящена данная статья. Этот организм представляет собой небольшой плеоморфный внутриэритроцитарный паразит, в основном связанный с разрушением эритроцитов. Хотя это не так часто встречается в районе Новой Англии, клиницисты должны знать о клинических признаках и лечении из-за растущей распространенности в ранее неэндемичных районах, а также из-за документации о присутствии бойцовых собак, в частности американских питбультерьеров.
Babesia gibsoni широко распространена среди американских питбулей, возможно потому, что передача может происходить через прямое заражение крови, включая совместное использование игл для вакцинации или повторное использование хирургических инструментов для купирования хвоста или купирования ушей.
Основной способ передачи организмов бабезии собакам — клещи во время кормления. Для этой передачи требуется 2–3 дня, и в США предполагаемым переносчиком является Rhipicephalus sanguineus .Нормальный инкубационный период составляет 7-21 день. Считается, что трансплацентарная передача также происходит, потому что B. gibsoni был обнаружен у щенков в возрасте 3 дней. Передача также может происходить через прямое заражение крови, что включает совместное использование игл для вакцинации или повторное использование хирургических инструментов для купирования хвоста или купирования ушей. Организм также может передаваться при собачьих боях. Все эти потенциальные способы передачи могут помочь объяснить высокую распространенность питбулей.В исследовании, посвященном неамериканским питбультерьерам, которым с помощью ПЦР был поставлен диагноз B. gibsoni, собак принадлежали к разным породам и имели схожие клинические результаты. Однако наиболее важно отметить, что 6 из 10 собак боролись с американским питбультерьером. Из-за возможности передачи через кровь все пациенты, используемые для сдачи крови, должны быть проверены на наличие Babesia spp.
Для этой передачи требуется 2–3 дня, и в США предполагаемым переносчиком является Rhipicephalus sanguineus .Нормальный инкубационный период составляет 7-21 день. Считается, что трансплацентарная передача также происходит, потому что B. gibsoni был обнаружен у щенков в возрасте 3 дней. Передача также может происходить через прямое заражение крови, что включает совместное использование игл для вакцинации или повторное использование хирургических инструментов для купирования хвоста или купирования ушей. Организм также может передаваться при собачьих боях. Все эти потенциальные способы передачи могут помочь объяснить высокую распространенность питбулей.В исследовании, посвященном неамериканским питбультерьерам, которым с помощью ПЦР был поставлен диагноз B. gibsoni, собак принадлежали к разным породам и имели схожие клинические результаты. Однако наиболее важно отметить, что 6 из 10 собак боролись с американским питбультерьером. Из-за возможности передачи через кровь все пациенты, используемые для сдачи крови, должны быть проверены на наличие Babesia spp.
B. gibsoni традиционно отличается от других распространенных организмов Babesia, встречающихся в U.S., Babesia canis , по мазкам крови. Организмы B. canis обычно крупнее (4-5 мкм, ) и выглядят как двулопастные грушевидные организмы, которые встречаются парами. B. gibsoni всего 1-2,5 мкм в диаметре и в красных кровяных тельцах выглядят как отдельные круглые или овальные или кольцеобразные организмы.
Острые клинические признаки бабезиоза собак включают летаргию, лихорадку, гемолитическую анемию, тромбоцитопению и спленомегалию. Эти результаты аналогичны тем, которые мы наблюдаем при иммуноопосредованной гемолитической анемии и тромбоцитопении, поэтому важно помнить об этом заболевании, когда сталкиваемся с этим проявлением.Хотя острая инфекция связана с тяжелой анемией и тромбоцитопенией, многие собаки переживают острую фазу и становятся хроническими носителями. Хронические инфекции очень распространены и могут иметь бессимптомный характер, однако эти домашние животные могут служить резервуарами болезней, и поэтому их все еще важно идентифицировать. Одно исследование показало, что 55% американских собак питбулей, испытанных в Алабаме, были инфицированы субклинически и, несмотря на отсутствие симптомов, имели более низкие показатели гематокрита и количества тромбоцитов по сравнению с отрицательными собаками.Несмотря на атипичность, имеется также одно сообщение о гломерулонефропатии, опосредованной иммунным комплексом, у собаки с положительной реакцией на B. gibsoni (с помощью ПЦР), поэтому бабезиоз следует добавить в дифференциальный список случаев нефропатии с потерей белка.
Хронические инфекции очень распространены и могут иметь бессимптомный характер, однако эти домашние животные могут служить резервуарами болезней, и поэтому их все еще важно идентифицировать. Одно исследование показало, что 55% американских собак питбулей, испытанных в Алабаме, были инфицированы субклинически и, несмотря на отсутствие симптомов, имели более низкие показатели гематокрита и количества тромбоцитов по сравнению с отрицательными собаками.Несмотря на атипичность, имеется также одно сообщение о гломерулонефропатии, опосредованной иммунным комплексом, у собаки с положительной реакцией на B. gibsoni (с помощью ПЦР), поэтому бабезиоз следует добавить в дифференциальный список случаев нефропатии с потерей белка.
Окончательный диагноз ставится на основании истории болезни, клинических признаков и идентификации бабезии в инфицированных эритроцитах, положительных серологических результатов и обнаружения амплификации экстракта нуклеиновой кислоты из крови или тканей (полимеразная цепная реакция; ПЦР).ПЦР-анализ в настоящее время является наиболее чувствительным методом выявления субклинических инфекций. Однако перекрестная реактивность между B. canis и B. gibsoni является переменной. Тест ПЦР для B. canis является специфическим и не обнаруживает другие виды, в то время как тест ПЦР для B. gibsoni может обнаруживать различные виды.
Лечение направлено на поддерживающую терапию, необходимую при остром проявлении анемии, и на попытку очистить организм. Для лечения и лечения бабезиоза собак использовались многие лекарственные препараты и комбинации лекарственных средств, включая бабезицидные препараты (диминазена ацетурат, имидокарб дипропионат), антибиотики и антипротозойные средства.На сегодняшний день, однако, ни одно лекарство не эффективно и последовательно устраняет B. gibsoni у инфицированных собак, а побочные эффекты, а также доступность некоторых лекарств ограничивают их использование. Многие специалисты по инфекционным заболеваниям в настоящее время рекомендуют комбинацию атоваквона и азитромицина, однако есть доказательства точечных мутаций в гене цитохрома b гена B. gibsoni , которые могут придавать устойчивость к атоваквону. Атоваквон также может ограничивать расходы для многих клиентов, и, несмотря на то, что доступны готовые формы, они могут быть не столь эффективными.Другие комбинации лекарственных препаратов, используемые с переменным успехом, включают: клиндамицин (отдельно), доксициклин / метронидазол / энрофлоксацин, атоваквон / прогуанил / доксициклин, клиндамицин / дименазен / имидокарб
Многие специалисты по инфекционным заболеваниям в настоящее время рекомендуют комбинацию атоваквона и азитромицина, однако есть доказательства точечных мутаций в гене цитохрома b гена B. gibsoni , которые могут придавать устойчивость к атоваквону. Атоваквон также может ограничивать расходы для многих клиентов, и, несмотря на то, что доступны готовые формы, они могут быть не столь эффективными.Другие комбинации лекарственных препаратов, используемые с переменным успехом, включают: клиндамицин (отдельно), доксициклин / метронидазол / энрофлоксацин, атоваквон / прогуанил / доксициклин, клиндамицин / дименазен / имидокарб
Риск заражения может быть снижен для собак, живущих в эндемичных районах, путем обеспечения агрессивной борьбы с клещами с помощью местного и перорального акарицида и ошейника от блох / клещей, а также ежедневного осмотра собак на наличие клещей, передача которых обычно занимает 2-3 дня кормления.
Таким образом, распространенность Babesia gibsoni по всей территории Соединенных Штатов растет, что требует повышения осведомленности всех ветеринаров.Хотя это обычно не наблюдается в районе Новой Англии, пациенты с совместимыми клинико-патологическими данными, историей собачьих боев или пациенты с историей путешествий должны рассматриваться для тестирования.
Для получения дополнительной информации, пожалуйста, свяжитесь со службой внутренней медицины Энджелла по телефону 617-541-5186 или по адресу [email protected].
Бабезиоз у собак
Что такое бабезийская инфекция?
Инфекция Babesia или бабезиоз означает инфицирование протозойным паразитом из вида Babesia . Мерозоитов или пироплазм — это стадия бабезии , которая проникает в эритроциты млекопитающих, вызывая анемию. Babesia видов встречаются во всем мире, хотя в Северной Америке большинство случаев бабезиоза среди собак встречается на юге Соединенных Штатов. Очаги болезни также существуют в Массачусетсе, Пенсильвании и Нью-Джерси.
Очаги болезни также существуют в Массачусетсе, Пенсильвании и Нью-Джерси.
Как собака заболевает бабезиозом?
Бабезиоз передается через укус инфицированного клеща (в основном от видов Ixodes , хотя другие виды клещей также могут быть переносчиками болезни).Есть также свидетельства того, что может происходить прямая передача вируса от животного к животному, например, когда инфицированная собака с поражениями или ссадинами полости рта кусает другую собаку. Недавние исследования показывают, что Babesia может передаваться трансплацентарно (нерожденным щенкам в матке). Собаки, содержащиеся в питомниках с плохой борьбой с клещами, подвержены более высокому риску развития бабезиоза.
Каковы клинические признаки бабезиоза?
Собаки, инфицированные бабезиозом, могут иметь широкий спектр клинических признаков, варьирующихся по степени тяжести от внезапного коллапса с системным шоком до гемолитического криза и коварной и медленно прогрессирующей инфекции без явных клинических признаков.У собак обычно наблюдается острая, тяжелая форма бабезиоза, которая характеризуется такими симптомами, как аномально темная моча, лихорадка, слабость, бледность слизистых оболочек, депрессия, лимфаденопатия (увеличение лимфатических узлов) и увеличение селезенки. Анализы крови и мочи могут показать анемию, тромбоцитопению (низкий уровень тромбоцитов), гипоальбуминемию (низкий уровень альбумина, белка крови) и билирубинурию.
Как диагностируется бабезиоз?
Раньше бабезиоз диагностировали путем выявления паразита в мазке крови.Другие диагностические тесты становятся все более доступными, включая окрашивание организма на FA (флуоресцентные антитела) и тесты ELISA (иммуноферментный анализ) (в настоящее время доступны только для B. canis ). Также доступен тест полимеразной цепной реакции (ПЦР).
Серологические тесты или тесты на титры при диагностике бабезиоза имеют ограничения. Положительный результат теста зависит от реакции инфицированной собаки антителами, для развития которой может потребоваться до десяти дней. После того, как у собаки выработались антитела к бабезиозу, они могут сохраняться годами, и это необходимо учитывать при проведении последующих анализов.
После того, как у собаки выработались антитела к бабезиозу, они могут сохраняться годами, и это необходимо учитывать при проведении последующих анализов.
Как лечится бабезиоз?
Средство лечения бабезиоза, одобренное FDA, — это дипропионат имидокарба . Другие методы лечения включают атоваквон (Mepron®) и азитромицин (Zithromax®). Эти новые методы лечения могут помочь устранить субклинические состояния носительства. Ваш ветеринар обсудит с вами любые альтернативные и дополнительные методы лечения.
Каков прогноз для собаки с диагнозом бабезиоз?
«Прогноз для собаки с диагнозом бабезиоз осторожный.Владельцы должны знать, что собаки, пережившие бабезиоз, часто остаются субклинически инфицированными «.
Прогноз для собаки с диагнозом бабезиоз остается осторожным. Владельцы должны знать, что собаки, пережившие бабезиоз, часто остаются субклинически инфицированными. Эти собаки могут пострадать от рецидива болезни в будущем или могут служить источником дальнейшего распространения болезни в данном районе. Собаки, выздоровевшие от бабезиоза, никогда не должны использоваться в качестве доноров для переливания крови, поскольку у реципиентов может развиться болезнь.
В настоящее время коммерчески недоступна эффективная вакцина для защиты собак от бабезиоза.
Профилактика, диагностика и лечение бабезиоза
Недавние сообщения о том, что в Великобритании был диагностирован Babesia canis , были особенно примечательны тем, что эти случаи касались небольшого количества собак в Эссексе, которые не выезжали за пределы Великобритании.Это напоминание о необходимости осознавать наличие трансмиссивных болезней не только у домашних животных, которые были за границей, но и у животных, которые не путешествовали.
Получив ряд запросов от членов, BSAVA подготовила ключевую информацию для профессионалов о профилактике, диагностике и лечении бабезиоза.
Вы можете найти эту информацию ниже вместе со ссылками и полезными ссылками.
Важно отметить, что владельцы собак, а также ветеринары могут отправлять любых клещей, которые они могут найти, в Систему регистрации клещей Министерства здравоохранения Англии или в Проект Big Tick для идентификации.
Babesia canis
Распространение
Бабезиоз обычно считался заболеванием, выявляемым у собак, возвращающихся из путешествия в Европу, хотя были сообщения о бабезиозе у неисследованных собак 4. Babesia spp. признаны во всем мире как внутриэритроцитарные клещевые простейшие паразиты. Babesia canis, Babesia gibsoni, Babesia vogeli и Babesia vulpes , как известно, заражают собак в Европе 3,5,9,10.
B. canis — это внутриэритроцитарный клещевой простейший паразит, эндемичный для большей части континентальной Европы. Он естественным образом передается клещами Dermacentor reticulatus , которые встречаются в Великобритании 7 , и клещами Rhipicephalus sanguineus , которые в настоящее время в Великобритании редки, но есть опасения, что они могут обосноваться здесь 1,2 , 6 , особенно после отмены необходимости обязательной обработки клещей перед въездом в Великобританию с изменением правил перевозки домашних животных 1 января 2012 г. 1,2. Сообщалось о передаче через переливание крови, трансплацентарный перенос и укусы собак. Кошачий бабезиоз был зарегистрирован в Южной Африке и Израиле 10 , с одним сообщением о случае кошки в Великобритании, у которой развился бабезиоз через 3 недели после импорта из Южной Африки 13.
Недавно B. canis у трех собак. в Эссексе без истории поездок за границу или контактов 11 и связанных клещей, было обнаружено APHA. 8
Презентация
Бабезиоз имеет широкий спектр клинических проявлений, которые различаются в зависимости от вида Babesia и хозяина 3,9, с бессимптомными носителями распознаются. Признаки могут быть от субклинических до острых и могут быть фатальными. Владельцы могут сообщать о летаргии, слабости и анорексии, бледности или желтухе. Типичные клинические проявления — пирексия, спленомегалия, гемолитическая анемия и тромбоцитопения 3,8.
Признаки могут быть от субклинических до острых и могут быть фатальными. Владельцы могут сообщать о летаргии, слабости и анорексии, бледности или желтухе. Типичные клинические проявления — пирексия, спленомегалия, гемолитическая анемия и тромбоцитопения 3,8.
Ветеринары должны учитывать возможность бабезиоза и других завозных болезней в качестве дифференциального диагноза при обращении к животному с совместимыми клиническими признаками, даже если нет данных о путешествиях.
Диагностика
B.canis может быть обнаружен путем прямой визуализации и идентификации микроорганизма по краям мазков крови, взятых из периферических капилляров (например, уколов в ушах). Обычно они встречаются парами и имеют грушевидную форму. B. gibsoni меньше по размеру и округлой формы. Не всегда можно увидеть организмы, и у больных животных обнаруживается более высокая диагностическая чувствительность по сравнению с субклинически инфицированными собаками или кошками.
Молекулярные методы, включая количественную ПЦР крови с ЭДТА, обеспечивают наиболее чувствительные и специфические диагностические тесты, они могут дать представление о патогенной нагрузке и позволяют идентифицировать виды, которые могут дать прогностическую информацию.Анализы могут варьироваться в зависимости от лаборатории, и могут возникать ложноположительные и отрицательные результаты. Тест должен включать внутренние положительные контроли для подтверждения успешного выделения нуклеиновой кислоты из исследуемого образца, отсутствия ингибирования и правильного функционирования реакции ПЦР, а также отрицательные контроли, чтобы избежать загрязнения ДНК. Генетическое секвенирование также доступно в специализированных лабораториях.
Серологические тесты не очень полезны, так как они могут указывать на воздействие в прошлом и не обязательно на текущую инфекцию, ложноотрицательные результаты могут иметь место на ранней стадии заболевания или у определенных видов, а также существует перекрестная реактивность с другими видами Babesia . 11
11
Точный диагноз наиболее вероятен при использовании нескольких диагностических тестов на патогены, включая микроскопическое исследование, серологию и молекулярные анализы. Более того, наличие сопутствующих инфекций или сопутствующих заболеваний может затруднить диагностику.
Передающиеся с кровью патогены могут оставаться жизнеспособными и заразными в продуктах крови в течение длительного времени, и доноры собачьей крови должны пройти соответствующий скрининг, предпочтительно с использованием нескольких методов 12.
Лечение
Имидокарб дипропионат (лицензирован для крупного рогатого скота как Imizol ) используется вне лицензии с информированного согласия на 6.6 мг / кг, вводимые в / м или п / к однократно и повторяющиеся через 14-21 день, считаются наиболее эффективным препаратом для потенциального выведения B. canis , но часто неэффективны при уничтожении более мелких видов Babesia . Безопасность и эффективность имидокарба не были полностью определены у щенков, разводимых, кормящих или беременных животных. Клиническое улучшение обычно наблюдается в течение 24–48 часов после начала лечения. Следует рассмотреть другие варианты поддерживающего лечения, включая переливание крови 5.
Лечение может не полностью уничтожить паразита, и собаки могут стать хроническими долгосрочными носителями. Этих собак нельзя использовать в качестве доноров крови. Заболевание может рецидивировать, если у таких собак будет иммуносупрессивная терапия или сопутствующее заболевание. 5
Профилактика
Избегание известных клещевых зон, особенно в «клещевые сезоны», использование эффективных средств против клещей и ежедневная проверка / эффективное удаление клещей могут помочь снизить риск передачи болезни.
Ссылки
1. Эбботт, Э. М., Артур, Дж., Эльшейха, М. А. и др. (2011) Отмена контроля за клещами для животных, ввозимых в Великобританию. Ветеринарный учет 169 , 394
2. Anon (2012) Клещи и клещевые болезни: повышение осведомленности о рисках. Ветеринарная запись 170, 351-352
3. Эйхенбергер, Р. М., Рионд, Б., Вилли, Б., et al. (2016) Прогностические маркеры при острой инфекции Babesia canis. Журнал внутренней ветеринарии 30 , 174-182
4.Холм, Л. П., Манро, Э. Р., Керр, М. Г. и др. (2006) Смертельный бабезиоз у неисследованной британской собаки. Ветеринарная запись 159 , 179-180
5. Ирвин П. Дж. (2009) Бабезиоз собак: от молекулярной систематики к контролю. Паразиты и переносчики 2 (Дополнение 1): S4 1-9
6. Джеймсон, Л. Дж., Фиппс, Л. П., и Медлок, Дж. М. (2010) Надзор за экзотическими клещами на домашних животных в Великобритании. Ветеринарная запись 166, 202-203
7. Медлок, Дж. М., Джеймсон, Л.Дж. И Фиппс, Л. П. (2011) Статус Dermacentor reticulatus в Великобритании. Ветеринарная запись 168, 386-387
8. Фиппс, Л. П., Фернандес де Марко, М. Д. М., Эрнандес-Триана, Л. М. и др. (2016) Babesia canis обнаружена у собак и связанных клещей из Эссекса. Ветеринарная запись 178, 243-244
9. Рене-Мартелле, М., Валиенте Моро, К., Шене, Дж. И др. (2015) Обновленная информация об эпидемиологии бабезиоза собак на юге Франции. BMC Veterinary Research 11 , 223-233
10.Солано-Гальего, Л. и Банет, Г. (2011) Бабезиоз у собак и кошек — Расширение паразитологического и клинического спектра. Ветеринарная паразитология 181, 48-60
11. Swainsbury, C., Bengtson, G. & Hill, P. (2016) Клещевые болезни: бабезиоз у собак Ветеринарная карта 178, 172
12. Wardrop, KJ , Reine, N., Birkenheuer, A., et al. (2005) Скрининг доноров крови собак и кошек на инфекционные заболевания. Журнал внутренней ветеринарной медицины 19 , 135-142
13.Wells, R. (2012) Бабезиоз у недавно завезенной кошки. Ветеринарный учет 171, 654
(2012) Бабезиоз у недавно завезенной кошки. Ветеринарный учет 171, 654
Полезная информация
Рекомендации ABCD по бабезиозу у кошек: рекомендации по профилактике и лечению
Краткая статья врача о бабезиозе
Борьба с паразитическими насекомыми и клещами у собак и кошек
Борьба с трансмиссивными заболеваниями у собак и кошек
Как пройти через джунгли лечения эктопаразитов для собак и кошек от Companion Январь 2012
Третье издание руководства BSAVA по клинической патологии собак и кошек будет включать главу о диагностике заболеваний, передаваемых протозойными и членистоногими. и будет доступен на Конгрессе BSAVA.
| Наши журналы | ||||||
| Как крупный международный издатель академических и исследовательских журналов Science Alert издает и разрабатывает названия в партнерстве с самыми престижные научные общества и издатели. Наша цель заключается в том, чтобы максимально широко использовать качественные исследования. аудитория. | ||||||
| Для авторов | ||||||
| Мы прилагаем все усилия, чтобы поддержать исследователей которые публикуют в наших журналах. Есть масса информации здесь, чтобы помочь вам публиковаться вместе с нами, а также ценные услуги для авторов, которые уже публиковались у нас. | ||||||
| Подписчикам | ||||||
2021 цены уже доступны. Ты
может получить личную / институциональную подписку перечисленных
журналы прямо из Science Alert. В качестве альтернативы вы
может пожелать связаться с выбранным вами агентством по подписке
Направляйте заказы, платежи и запросы в службу поддержки.
в службу поддержки клиентов журнала Science Alert. Ты
может получить личную / институциональную подписку перечисленных
журналы прямо из Science Alert. В качестве альтернативы вы
может пожелать связаться с выбранным вами агентством по подписке
Направляйте заказы, платежи и запросы в службу поддержки.
в службу поддержки клиентов журнала Science Alert. | ||||||
| Для обществ | ||||||
| Science Alert гордится своей тесные и прозрачные отношения с обществом.В качестве некоммерческий издатель, мы стремимся к самому широкому возможное распространение публикуемых нами материалов и на предоставление услуг высочайшего качества нашим издательские партнеры. | ||||||
| Справочный центр | ||||||
| Здесь вы найдете ответы на наиболее часто задаваемые вопросы (FAQ), которые мы получили по электронной почте или через контактную форму в Интернете.В зависимости от характера вопросов мы разделили часто задаваемые вопросы на разные категории. | ||||||
| База данных ASCI | ||||||
Азиатский индекс научного цитирования (ASCI)
стремится предоставить авторитетный, надежный и
значимая информация по освещению наиболее важных
и влиятельные журналы для удовлетворения потребностей мировых
научное сообщество. Iconic One Theme | Powered by Wordpress
| ||||||